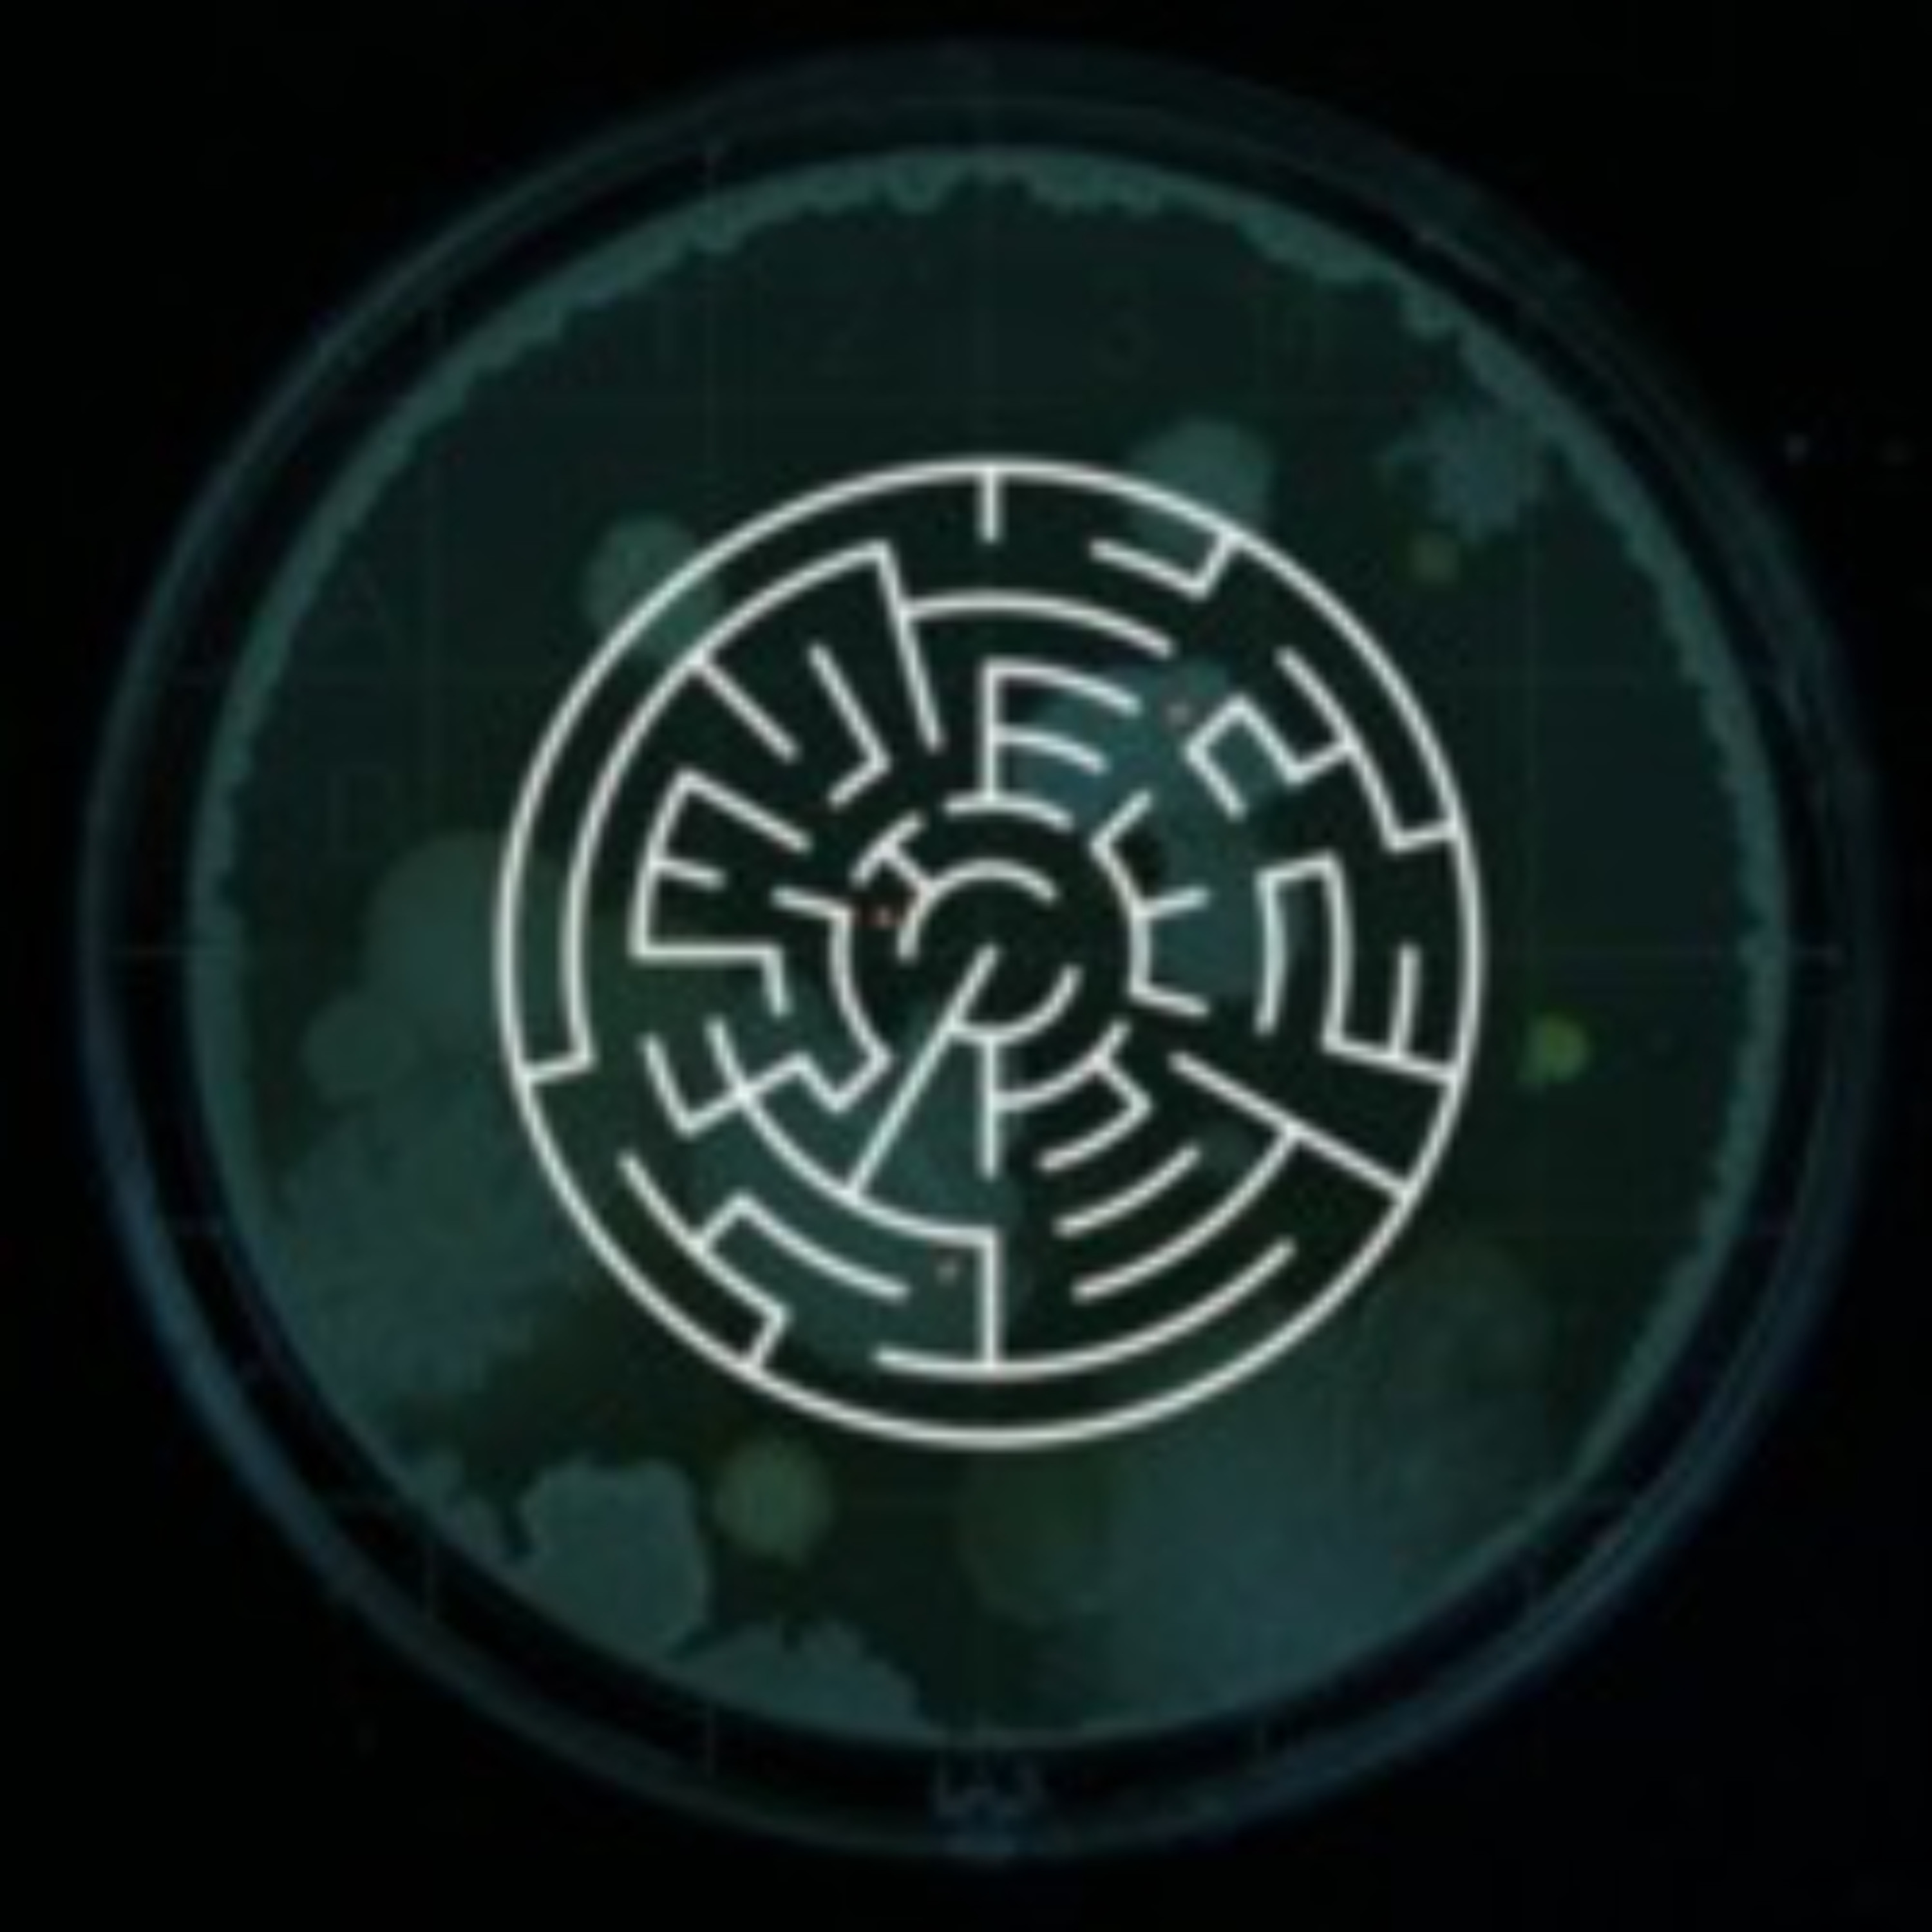
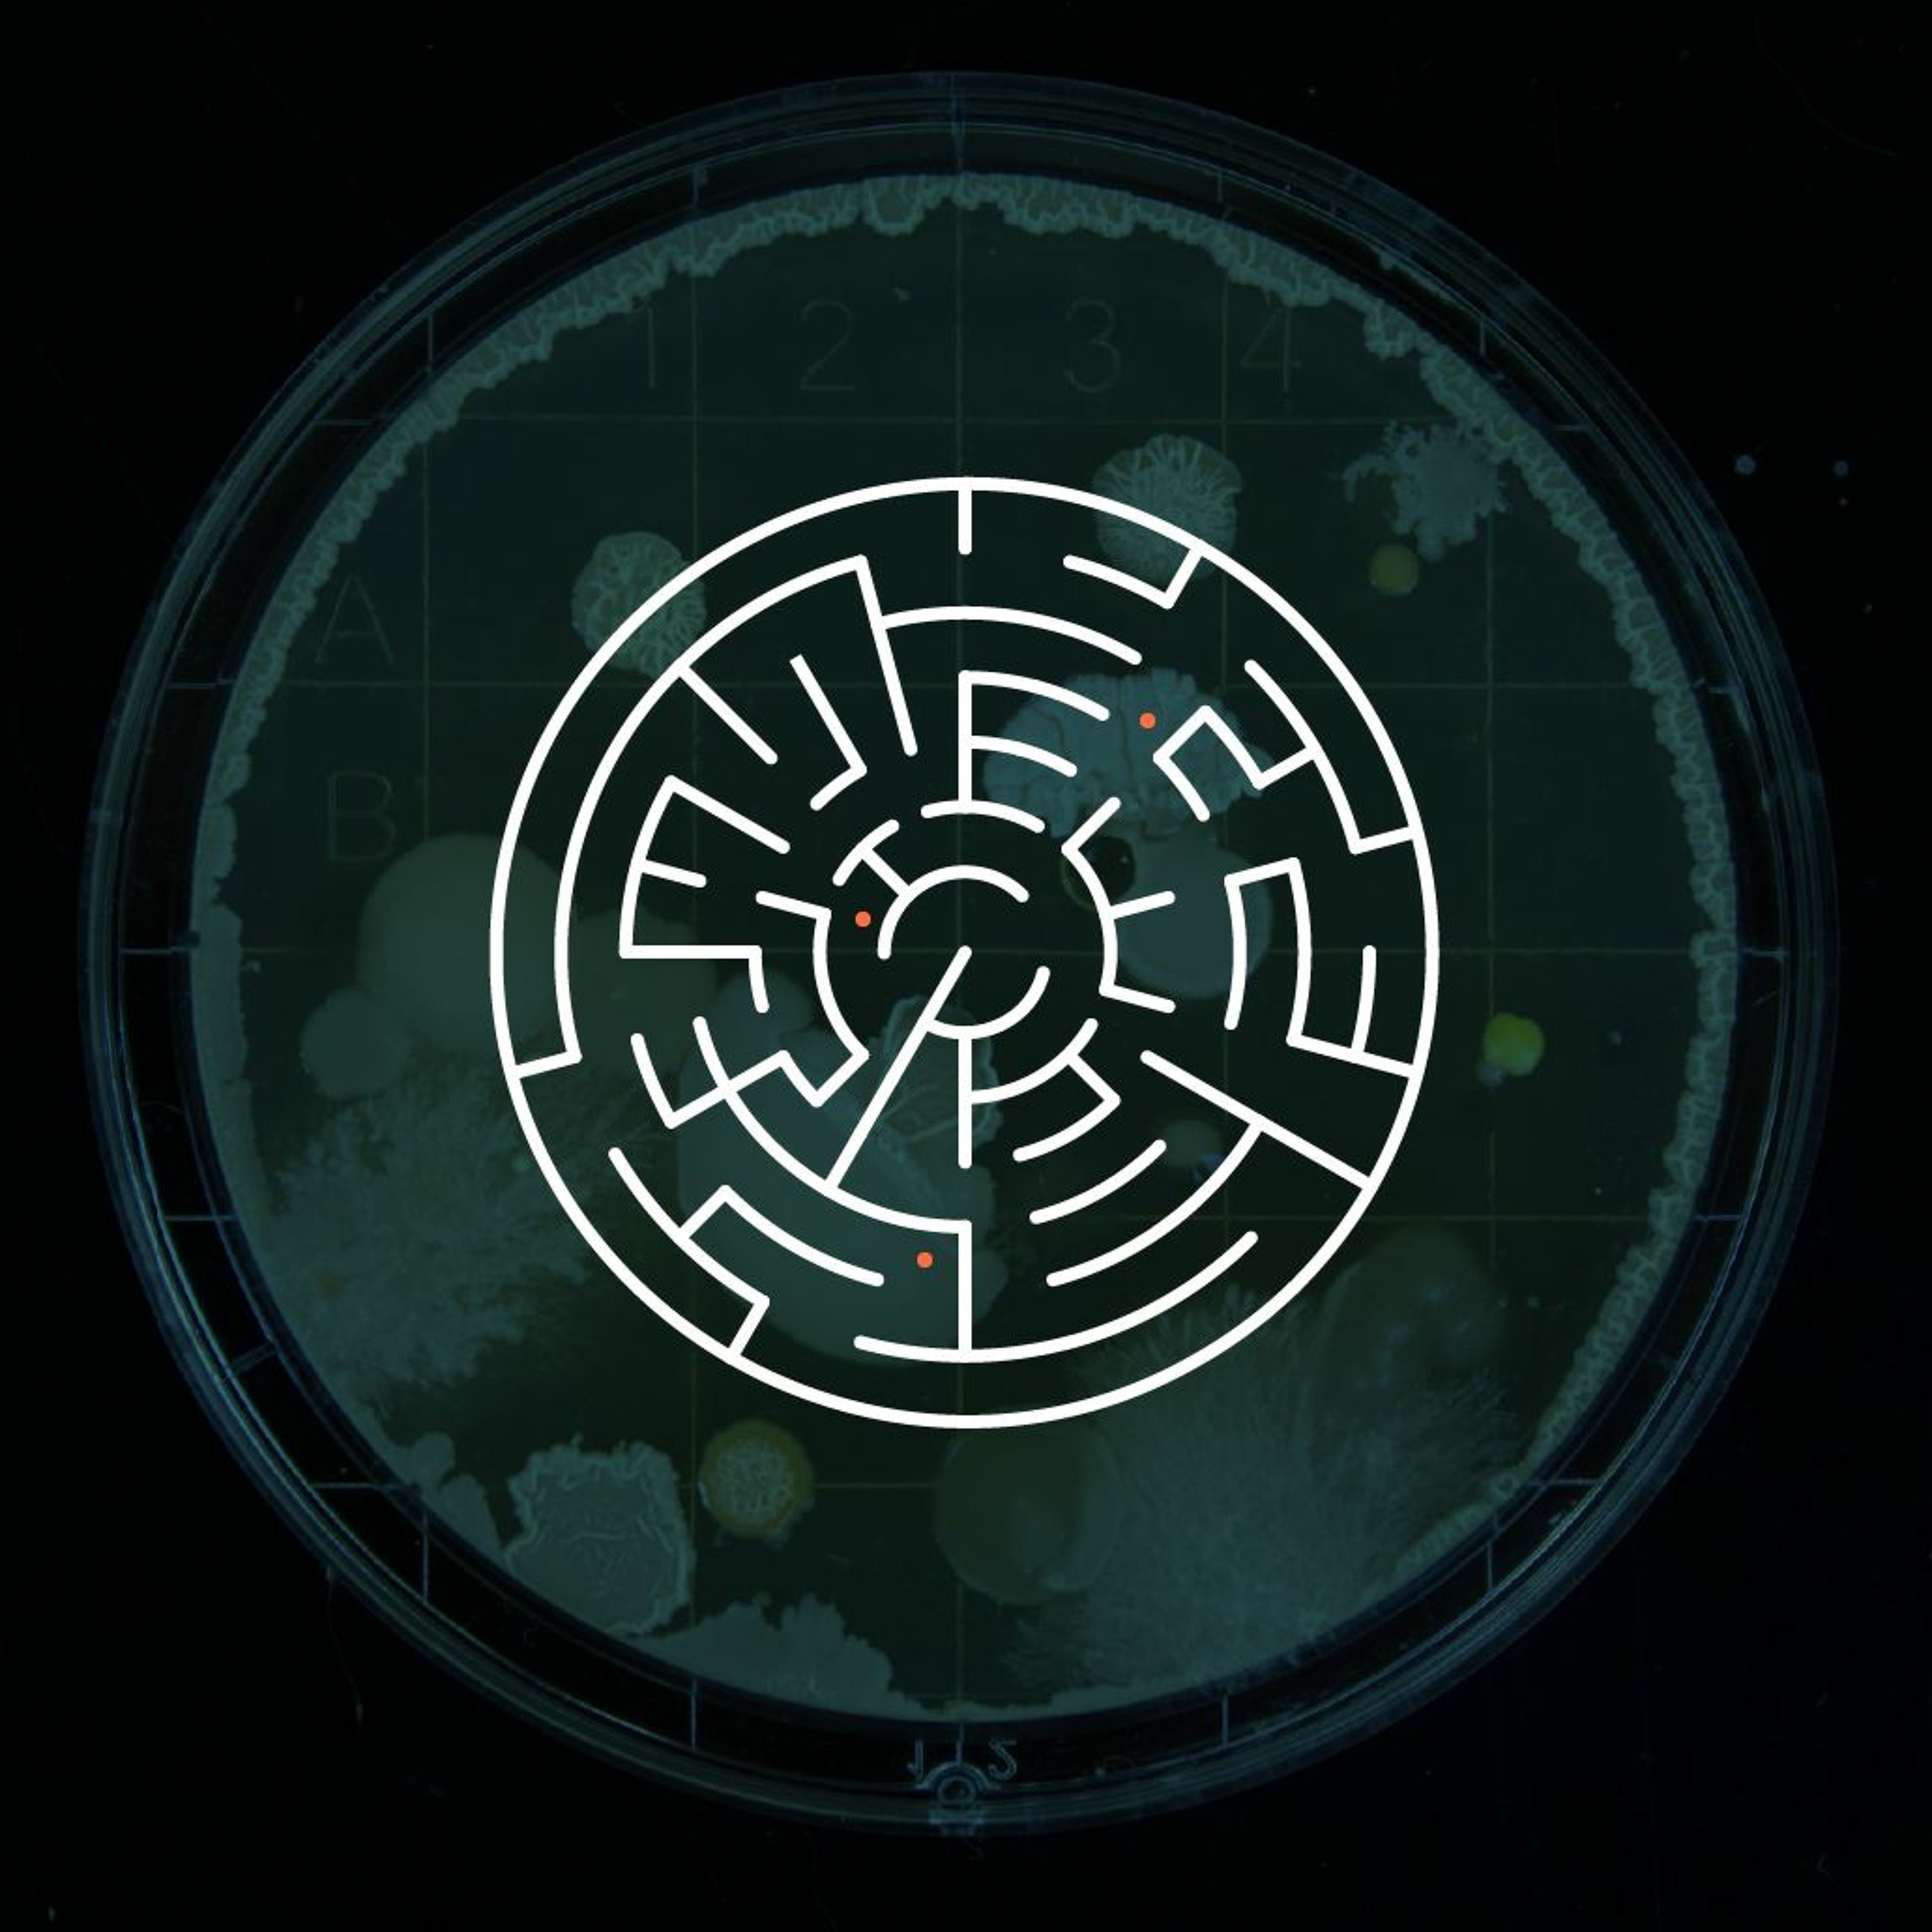

Shows
 The Business of AI20. Reviewing the AI Opportunities Action Plan: 6 Month ScorecardIn this special live episode of the UKAI Podcast filmed at UKAI's 6 Month Review of the AI Opportunities Action Plan, Tim Flagg is joined by two of the UK’s leading policy voices Dr Erin Young, Head of Tech Policy at the Institute of Directors, and Jakob Mökander, Director of Science & Technology Policy at the Tony Blair Institute, for a deep-dive fireside chat assessing delivery, direction and what's missing.They explore:Where progress has been made – and where momentum is stallingRegional development, AI skills, immigration, procurement and computeWhy fewer, bolder KPIs could be key to effec...2025-07-3025 min
The Business of AI20. Reviewing the AI Opportunities Action Plan: 6 Month ScorecardIn this special live episode of the UKAI Podcast filmed at UKAI's 6 Month Review of the AI Opportunities Action Plan, Tim Flagg is joined by two of the UK’s leading policy voices Dr Erin Young, Head of Tech Policy at the Institute of Directors, and Jakob Mökander, Director of Science & Technology Policy at the Tony Blair Institute, for a deep-dive fireside chat assessing delivery, direction and what's missing.They explore:Where progress has been made – and where momentum is stallingRegional development, AI skills, immigration, procurement and computeWhy fewer, bolder KPIs could be key to effec...2025-07-3025 min The Business of AI19. Responsible AI, Boardroom Strategy & Women in AI Leadership with Zahra ShahIn this episode of The Business of AI, Tim Flagg speaks with Zahra Shah, AI and frontier tech board advisor, founder, and UKAI lead on women in AI to explore how organisations can embed governance, trust and inclusion into the heart of their AI strategies.Zahra shares lessons from working with regulators like the ICO, partnering with IBM on responsible enterprise tools, and deploying AI assistants that streamline legal and HR processes. She explains how small models, explainable AI, and robust accountability frameworks are not just for big tech they’re essential for start-ups too.Th...2025-07-2928 min
The Business of AI19. Responsible AI, Boardroom Strategy & Women in AI Leadership with Zahra ShahIn this episode of The Business of AI, Tim Flagg speaks with Zahra Shah, AI and frontier tech board advisor, founder, and UKAI lead on women in AI to explore how organisations can embed governance, trust and inclusion into the heart of their AI strategies.Zahra shares lessons from working with regulators like the ICO, partnering with IBM on responsible enterprise tools, and deploying AI assistants that streamline legal and HR processes. She explains how small models, explainable AI, and robust accountability frameworks are not just for big tech they’re essential for start-ups too.Th...2025-07-2928 min The Business of AI18. Hacking Humanity: Lara Lewington on How AI Can Save Your Health and Your LifeIn this special live recording of the UKAI Business of AI Podcast, UKAI CEO Tim Flagg is joined by technology journalist and broadcaster Lara Lewington to discuss her new book, Hacking Humanity: How Technology Can Save Your Health and Your Life.With decades of experience reporting on emerging technologies, Lara shares the personal stories, scientific breakthroughs, and global insights that shaped her book. From genome sequencing and wearable tech to data ethics and AI-powered diagnosis, she highlights how healthcare is being radically transformed and why putting people first is essential to making that transformation meaningful....2025-07-1424 min
The Business of AI18. Hacking Humanity: Lara Lewington on How AI Can Save Your Health and Your LifeIn this special live recording of the UKAI Business of AI Podcast, UKAI CEO Tim Flagg is joined by technology journalist and broadcaster Lara Lewington to discuss her new book, Hacking Humanity: How Technology Can Save Your Health and Your Life.With decades of experience reporting on emerging technologies, Lara shares the personal stories, scientific breakthroughs, and global insights that shaped her book. From genome sequencing and wearable tech to data ethics and AI-powered diagnosis, she highlights how healthcare is being radically transformed and why putting people first is essential to making that transformation meaningful....2025-07-1424 min The Business of AI17. Everyday AI, Empowerment and Inclusive Design with Mave SocialIn this episode, Tim welcomes Sumathi Menon, founder of Mave Social, to explore how everyday efficiencies and inclusive design are reshaping the AI experience. With a focus on practical impact, Sumathi shares how tools like AI generated presentations are streamlining once tedious workflows while emphasising the importance of human oversight, expertise and intentional design.They discuss the shift from blank page paralysis to AI assisted creativity, the risk of quality decay in generative content, and the need for users to remain discerning stewards of output. Sumathi also introduces the mission of Mave Social, democratising AI learning and...2025-06-2432 min
The Business of AI17. Everyday AI, Empowerment and Inclusive Design with Mave SocialIn this episode, Tim welcomes Sumathi Menon, founder of Mave Social, to explore how everyday efficiencies and inclusive design are reshaping the AI experience. With a focus on practical impact, Sumathi shares how tools like AI generated presentations are streamlining once tedious workflows while emphasising the importance of human oversight, expertise and intentional design.They discuss the shift from blank page paralysis to AI assisted creativity, the risk of quality decay in generative content, and the need for users to remain discerning stewards of output. Sumathi also introduces the mission of Mave Social, democratising AI learning and...2025-06-2432 min The Business of AI16. From Data to Intent: AI That Understands You, with Jonathan Lakin from IntentHQTim Flagg speaks with Jonathan Lakin, CEO and Founder of IntentHQ, about unlocking the power of AI through deep understanding of human behaviour.Jonathan shares his fascinating journey from studying typography to pioneering AI-driven behavioural insights that help organisations create hyper-personalised customer experiences. They explore how Intent HQ uses proprietary AI models, focusing not just on language but on actual user behaviour, to drive relevance, reduce spam, and increase customer engagement.Key topics include:* The evolution of AI from machine learning to agentic systems.* Intent HQ’s suite of behavioural AIs and on...2025-06-1739 min
The Business of AI16. From Data to Intent: AI That Understands You, with Jonathan Lakin from IntentHQTim Flagg speaks with Jonathan Lakin, CEO and Founder of IntentHQ, about unlocking the power of AI through deep understanding of human behaviour.Jonathan shares his fascinating journey from studying typography to pioneering AI-driven behavioural insights that help organisations create hyper-personalised customer experiences. They explore how Intent HQ uses proprietary AI models, focusing not just on language but on actual user behaviour, to drive relevance, reduce spam, and increase customer engagement.Key topics include:* The evolution of AI from machine learning to agentic systems.* Intent HQ’s suite of behavioural AIs and on...2025-06-1739 min The Business of AI15. Agentic AI & Societal Shifts: Balancing Speed, Ethics & Impact with SagittalIn this episode, Tim welcomes Michael Smith, CEO of Sagittal AI, for a wide-ranging discussion on how agentic AI is reshaping business and society. Drawing parallels with the industrial revolution, Michael unpacks the scale and speed of today’s AI transformation and the urgent need for proactive, ethical frameworks to guide it.They explore the dual forces at play: the commercial opportunities created by AI and the risk of exacerbating inequality if left unchecked. Michael shares how Sagittal is working at the intersection of enterprise enablement and societal responsibility, helping organisations navigate this evolving landscape with purpose an...2025-06-1229 min
The Business of AI15. Agentic AI & Societal Shifts: Balancing Speed, Ethics & Impact with SagittalIn this episode, Tim welcomes Michael Smith, CEO of Sagittal AI, for a wide-ranging discussion on how agentic AI is reshaping business and society. Drawing parallels with the industrial revolution, Michael unpacks the scale and speed of today’s AI transformation and the urgent need for proactive, ethical frameworks to guide it.They explore the dual forces at play: the commercial opportunities created by AI and the risk of exacerbating inequality if left unchecked. Michael shares how Sagittal is working at the intersection of enterprise enablement and societal responsibility, helping organisations navigate this evolving landscape with purpose an...2025-06-1229 min The Business of AI14. Automate, Optimise, Empower: Human-Centred AI with AI TappersIn this episode, Tim welcomes Marcus Cronan and Mattias Herzig, co-founders of AI Tappers, to explore how automation and AI-driven research are reshaping how teams work without losing the human touch. Combining deep technical know-how with a coaching mindset, Marcus and Mattias share how they help organisations reclaim time, improve decision-making, and unlock higher-value contributions from their people.They explain how AI Tappers builds systems that turn 40-hour research tasks into 10-minute workflows—allowing employees to focus on strategy, creativity, and engagement. With examples from their work with analysts and client-facing teams, the conversation highlights the real RO...2025-06-0634 min
The Business of AI14. Automate, Optimise, Empower: Human-Centred AI with AI TappersIn this episode, Tim welcomes Marcus Cronan and Mattias Herzig, co-founders of AI Tappers, to explore how automation and AI-driven research are reshaping how teams work without losing the human touch. Combining deep technical know-how with a coaching mindset, Marcus and Mattias share how they help organisations reclaim time, improve decision-making, and unlock higher-value contributions from their people.They explain how AI Tappers builds systems that turn 40-hour research tasks into 10-minute workflows—allowing employees to focus on strategy, creativity, and engagement. With examples from their work with analysts and client-facing teams, the conversation highlights the real RO...2025-06-0634 min The Business of AI13. Tech for Good: Empathy, Ethics & Youth in AI with OneHiveIn this episode, Tim speaks with Rushab Shah, founder of OneHive, about how AI can be a force for good—particularly when grounded in empathy, ethics, and inclusion. They explore the shifting expectations of a new generation, why values-led organisations are outperforming the market, and how social impact and commercial success are no longer at odds.Rushab shares how OneHive is empowering young people and building technology that responds to real societal needs, from digital inclusion to emotional intelligence in leadership. They reflect on the cultural transformation underway across the tech industry, the commercial case for responsible in...2025-06-0531 min
The Business of AI13. Tech for Good: Empathy, Ethics & Youth in AI with OneHiveIn this episode, Tim speaks with Rushab Shah, founder of OneHive, about how AI can be a force for good—particularly when grounded in empathy, ethics, and inclusion. They explore the shifting expectations of a new generation, why values-led organisations are outperforming the market, and how social impact and commercial success are no longer at odds.Rushab shares how OneHive is empowering young people and building technology that responds to real societal needs, from digital inclusion to emotional intelligence in leadership. They reflect on the cultural transformation underway across the tech industry, the commercial case for responsible in...2025-06-0531 min The Business of AI12. Responsible AI: Testing, Transparency and Trust with Intellect FrontierIn this episode, Tim welcomes Matt Holmes, founder of Intellect Frontier, to explore how organisations can embed responsible AI practices from the ground up. Drawing on his expertise in red teaming, systemic testing, and AI deployment standards, Matt outlines a practical framework for building transparency, trust, and traceability into AI systems especially those used in high-consequence sectors like healthcare and education.They discuss the critical importance of rigorous pre- and post-deployment testing, why data transparency must extend beyond the model to include everything built on top of it, and how standards could guide the future of AI...2025-06-0329 min
The Business of AI12. Responsible AI: Testing, Transparency and Trust with Intellect FrontierIn this episode, Tim welcomes Matt Holmes, founder of Intellect Frontier, to explore how organisations can embed responsible AI practices from the ground up. Drawing on his expertise in red teaming, systemic testing, and AI deployment standards, Matt outlines a practical framework for building transparency, trust, and traceability into AI systems especially those used in high-consequence sectors like healthcare and education.They discuss the critical importance of rigorous pre- and post-deployment testing, why data transparency must extend beyond the model to include everything built on top of it, and how standards could guide the future of AI...2025-06-0329 min The Business of AI11. Executive Assistants and AI: How Carve is Redefining the EA RoleIn this episode, Tim welcomes Fiona Young, founder of Carve AI, to explore how executive assistants are becoming strategic enablers in the AI era. With Carve’s mission to empower the world’s top EAs through hands-on, practical AI training, Fiona shares how her learners are not only improving productivity but stepping into broader, more influential roles across organisations.Drawing on years of foresight and deep practitioner experience, Fiona discusses the transformation of the EA function from traditional support roles to strategic operations, internal communications, and even chief-of-staff-style responsibilities. She and Tim explore how AI is unlocking new...2025-06-0232 min
The Business of AI11. Executive Assistants and AI: How Carve is Redefining the EA RoleIn this episode, Tim welcomes Fiona Young, founder of Carve AI, to explore how executive assistants are becoming strategic enablers in the AI era. With Carve’s mission to empower the world’s top EAs through hands-on, practical AI training, Fiona shares how her learners are not only improving productivity but stepping into broader, more influential roles across organisations.Drawing on years of foresight and deep practitioner experience, Fiona discusses the transformation of the EA function from traditional support roles to strategic operations, internal communications, and even chief-of-staff-style responsibilities. She and Tim explore how AI is unlocking new...2025-06-0232 min The Business of AI10. Building AI Foundations: Fixing Flow, Structure & Strategy with LumoIn this episode, Tim welcomes Joe and Krantik, co-founders of Lumo, to explore how organisations can transition successfully into the AI era. Drawing on over 15 years of transformation expertise, they discuss the critical elements beyond the tech, why clarity of purpose, data readiness, architecture, operating models, and workforce enablement are vital to avoid “AI for the sake of AI.” Lumo's experience, spanning sectors like healthcare, retail, and media reveals the importance of strategic alignment, organisational readiness, and people-first design. They also touch on upcoming shifts including AI agents and the increasing clarity around governance and trust, which they believe will...2025-05-3036 min
The Business of AI10. Building AI Foundations: Fixing Flow, Structure & Strategy with LumoIn this episode, Tim welcomes Joe and Krantik, co-founders of Lumo, to explore how organisations can transition successfully into the AI era. Drawing on over 15 years of transformation expertise, they discuss the critical elements beyond the tech, why clarity of purpose, data readiness, architecture, operating models, and workforce enablement are vital to avoid “AI for the sake of AI.” Lumo's experience, spanning sectors like healthcare, retail, and media reveals the importance of strategic alignment, organisational readiness, and people-first design. They also touch on upcoming shifts including AI agents and the increasing clarity around governance and trust, which they believe will...2025-05-3036 min The Business of AI9. Designing AI for Humans: How Nile Builds Trust-Centred, AI-Native OrganisationsIn this episode, Neil Coleman, Design Director at Nile, shares how his team helps organisations navigate AI transformation through a human-centred lens. With roots in UX and service design, Nile has spent nearly 20 years understanding how people interact with evolving technology, from the rise of smartphones to the adoption of AI. Neil explains how they now use data-driven methodologies to prioritise AI opportunities, while deeply considering employee and customer experiences. From wealth management to marketing compliance, Nile’s work ensures that AI doesn’t just speed things up, it enhances trust, usab...2025-05-2925 min
The Business of AI9. Designing AI for Humans: How Nile Builds Trust-Centred, AI-Native OrganisationsIn this episode, Neil Coleman, Design Director at Nile, shares how his team helps organisations navigate AI transformation through a human-centred lens. With roots in UX and service design, Nile has spent nearly 20 years understanding how people interact with evolving technology, from the rise of smartphones to the adoption of AI. Neil explains how they now use data-driven methodologies to prioritise AI opportunities, while deeply considering employee and customer experiences. From wealth management to marketing compliance, Nile’s work ensures that AI doesn’t just speed things up, it enhances trust, usab...2025-05-2925 min The Business of AI8. Passion Lab - Solving Hard Problems with AI: Creativity, Strategy & Cutting-Edge ToolsIn this episode, Tom and Nadine from Passion Lab reveal how their AI R&D lab tackles unsolved and complex problems across sectors, from creative industries to structural engineering. They discuss helping businesses adopt AI through audits, data readiness assessments, and bespoke tool development. Nadine shares how Passion Lab uses AI to detect emerging music trends, improve semantic search, and enhance recommendation systems. They also explore why LLMs aren’t always the answer, the role of synthetic data, and the promise (and limitations) of agentic systems. With deep roots in applied machine learning, the team em...2025-05-2828 min
The Business of AI8. Passion Lab - Solving Hard Problems with AI: Creativity, Strategy & Cutting-Edge ToolsIn this episode, Tom and Nadine from Passion Lab reveal how their AI R&D lab tackles unsolved and complex problems across sectors, from creative industries to structural engineering. They discuss helping businesses adopt AI through audits, data readiness assessments, and bespoke tool development. Nadine shares how Passion Lab uses AI to detect emerging music trends, improve semantic search, and enhance recommendation systems. They also explore why LLMs aren’t always the answer, the role of synthetic data, and the promise (and limitations) of agentic systems. With deep roots in applied machine learning, the team em...2025-05-2828 min The Business of AI7. True Rights - Protecting Talent in the Age of AI: Rights, Likeness & GenAI with Ben WoollamsIn this episode, Ben, founder and CEO of True Rights, reveals how his platform is pioneering digital rights management in the AI era, focusing on protecting talent’s likeness, IP, and digital identity. As generative AI tools become increasingly capable of replicating real people, down to scars, voices, and mannerisms, Ben explains how this technology is being used (and misused) by brands and creators alike.He shares insights into building ethical frameworks for licensing digital twins, developing partnerships with GenAI platforms, and embedding rights directly into media through True Rights’ proprietary tech...2025-05-2732 min
The Business of AI7. True Rights - Protecting Talent in the Age of AI: Rights, Likeness & GenAI with Ben WoollamsIn this episode, Ben, founder and CEO of True Rights, reveals how his platform is pioneering digital rights management in the AI era, focusing on protecting talent’s likeness, IP, and digital identity. As generative AI tools become increasingly capable of replicating real people, down to scars, voices, and mannerisms, Ben explains how this technology is being used (and misused) by brands and creators alike.He shares insights into building ethical frameworks for licensing digital twins, developing partnerships with GenAI platforms, and embedding rights directly into media through True Rights’ proprietary tech...2025-05-2732 min The Business of AI6. Digica - Putting data science at the heart of solutions from finding meth-labs to detecting rust and moreIn this episode we’re joined by Jim Carroll, founder of Digica, to explore the practical realities of deploying AI in business. Jim shares how Digica stands apart with a data science-first approach, building AI solutions from scratch and integrating them into real-world software. He explains the challenges of handling messy legacy data, the emerging role of synthetic data, and how Digica has applied AI to projects ranging from detecting rust in industrial settings to identifying meth labs with computer vision. Jim also discusses the shift from experimentation to scalable solutions, and how Digica helps clients turn AI...2025-05-2622 min
The Business of AI6. Digica - Putting data science at the heart of solutions from finding meth-labs to detecting rust and moreIn this episode we’re joined by Jim Carroll, founder of Digica, to explore the practical realities of deploying AI in business. Jim shares how Digica stands apart with a data science-first approach, building AI solutions from scratch and integrating them into real-world software. He explains the challenges of handling messy legacy data, the emerging role of synthetic data, and how Digica has applied AI to projects ranging from detecting rust in industrial settings to identifying meth labs with computer vision. Jim also discusses the shift from experimentation to scalable solutions, and how Digica helps clients turn AI...2025-05-2622 min The Business of AI5. Deep Infinity - Revolutionising Healthcare Diagnosis with AIWe speak with Rama and Prasanthi, co-founders of Deep Infinity, a pioneering company revolutionising healthcare. They share how their proprietary AI tools are helping clinicians streamline workflows, reduce diagnostic errors, and prioritise urgent cases, without ever removing the human from the loop. From transforming chest X-ray analysis to tackling documentation burdens and ensuring data privacy, they explore the real-world impact of AI in improving patient outcomes. We also discuss bridging the cultural and operational gap between technologists and medical professionals, the regulatory hurdles of scaling in healthcare, and the future of multimodal diagnostics and AI-powered medical agents. Tune in...2025-05-2624 min
The Business of AI5. Deep Infinity - Revolutionising Healthcare Diagnosis with AIWe speak with Rama and Prasanthi, co-founders of Deep Infinity, a pioneering company revolutionising healthcare. They share how their proprietary AI tools are helping clinicians streamline workflows, reduce diagnostic errors, and prioritise urgent cases, without ever removing the human from the loop. From transforming chest X-ray analysis to tackling documentation burdens and ensuring data privacy, they explore the real-world impact of AI in improving patient outcomes. We also discuss bridging the cultural and operational gap between technologists and medical professionals, the regulatory hurdles of scaling in healthcare, and the future of multimodal diagnostics and AI-powered medical agents. Tune in...2025-05-2624 min The Business of AI2. Ignite AI Partners - Grow Your Business with AIStruggling to turn AI hype into real business value? You're not alone. In this episode of the UK AI Podcast, we cut through the noise with Neil Holden and Craig Bentley, co-founders of Ignite AI Partners, who share brutally honest insights from years of experience helping major enterprises adopt AI the right way.Learn why so many AI projects fail, and what successful companies do differently—from aligning AI to business goals and overcoming legacy system headaches, to building internal buy-in and avoiding the “AI as magic” mindset. You’ll hear real-world examples of how AI has d...2025-05-1733 min
The Business of AI2. Ignite AI Partners - Grow Your Business with AIStruggling to turn AI hype into real business value? You're not alone. In this episode of the UK AI Podcast, we cut through the noise with Neil Holden and Craig Bentley, co-founders of Ignite AI Partners, who share brutally honest insights from years of experience helping major enterprises adopt AI the right way.Learn why so many AI projects fail, and what successful companies do differently—from aligning AI to business goals and overcoming legacy system headaches, to building internal buy-in and avoiding the “AI as magic” mindset. You’ll hear real-world examples of how AI has d...2025-05-1733 min The Business of AI3. What’s Really Stopping Your Business from Using AI — And How to Fix It. Join James Hutt from Paradigm JunctionThink AI success is all about hiring data scientists or buying the latest tools? Think again. In this episode, James Hutt, founder of Paradigm Junction, shares real stories from the front lines of AI transformation and reveals why incentives, leadership, and culture matter more than the tech itself.You’ll learn how forward-thinking businesses are outpacing the competition by aligning internal incentives, creating space for experimentation, and empowering teams at all levels, not just technology teams. Discover what works (and what fails) when trying to introduce AI into established organisations, and how to le...2025-05-1726 min
The Business of AI3. What’s Really Stopping Your Business from Using AI — And How to Fix It. Join James Hutt from Paradigm JunctionThink AI success is all about hiring data scientists or buying the latest tools? Think again. In this episode, James Hutt, founder of Paradigm Junction, shares real stories from the front lines of AI transformation and reveals why incentives, leadership, and culture matter more than the tech itself.You’ll learn how forward-thinking businesses are outpacing the competition by aligning internal incentives, creating space for experimentation, and empowering teams at all levels, not just technology teams. Discover what works (and what fails) when trying to introduce AI into established organisations, and how to le...2025-05-1726 min The Business of AI4. From Gaming to AI Avatars: How SKC Games Is Reinventing Customer Experience with Ethical AIWhat if the future of customer service, retail, heritage, and hospitality was powered by emotionally intelligent AI avatars? In this fascinating episode, we talk to Asa and Babita from SKC Games, the innovative team behind AI characters that are transforming industries, starting with a video game prototype and evolving into powerful, multilingual digital assistants.Discover how SKC Games uses AI to create deeply personalised, emotionally resonant experiences that serve customers with empathy in different languages, while protecting user privacy, ensuring historical accuracy, and putting ethics and trust at the heart of their...2025-05-1729 min
The Business of AI4. From Gaming to AI Avatars: How SKC Games Is Reinventing Customer Experience with Ethical AIWhat if the future of customer service, retail, heritage, and hospitality was powered by emotionally intelligent AI avatars? In this fascinating episode, we talk to Asa and Babita from SKC Games, the innovative team behind AI characters that are transforming industries, starting with a video game prototype and evolving into powerful, multilingual digital assistants.Discover how SKC Games uses AI to create deeply personalised, emotionally resonant experiences that serve customers with empathy in different languages, while protecting user privacy, ensuring historical accuracy, and putting ethics and trust at the heart of their...2025-05-1729 min The Business of AI1. Digitalent - Helping businesses identify the skills and talent they need to succeed in the AI age🎧 Why AI Talent Is the #1 Growth Challenge for Businesses (and How to Solve It)AI tools are evolving fast—but if your company can’t hire or retain the right talent, you’re already falling behind. In this episode, we speak with Chris Morrow, founder of specialist AI recruitment firm DigiTalent, about how businesses can compete globally for top AI professionals and what’s holding many back.You’ll learn:Why the real AI bottleneck is people, not techWhat roles companies are hiring for (AI engineers, ML ops, data architec...2025-05-1336 min
The Business of AI1. Digitalent - Helping businesses identify the skills and talent they need to succeed in the AI age🎧 Why AI Talent Is the #1 Growth Challenge for Businesses (and How to Solve It)AI tools are evolving fast—but if your company can’t hire or retain the right talent, you’re already falling behind. In this episode, we speak with Chris Morrow, founder of specialist AI recruitment firm DigiTalent, about how businesses can compete globally for top AI professionals and what’s holding many back.You’ll learn:Why the real AI bottleneck is people, not techWhat roles companies are hiring for (AI engineers, ML ops, data architec...2025-05-1336 min the fahrenheit performance podcastepisode 71 : japanese secret special sauceWe welcomed Kayato Ukai, a Japanese triathlete who loves to push the limits to the red seats this week.Originally from Kawanishi 川西市, in Hyogo prefecture, Japan, Kayato moved to Singapore to bring the supplement brand SAURUS to SE Asia. In a short few months he has made is presence felt personally by his great performances in the local endurance scene and also professionally but opening the door for the brand by establishing locally. The fortnightly run club that Kayato and Saurus have set up has been affectionately known as the "Shinkansen Run" because of its Japanese origins and its rapid pace...2025-05-1236 min
the fahrenheit performance podcastepisode 71 : japanese secret special sauceWe welcomed Kayato Ukai, a Japanese triathlete who loves to push the limits to the red seats this week.Originally from Kawanishi 川西市, in Hyogo prefecture, Japan, Kayato moved to Singapore to bring the supplement brand SAURUS to SE Asia. In a short few months he has made is presence felt personally by his great performances in the local endurance scene and also professionally but opening the door for the brand by establishing locally. The fortnightly run club that Kayato and Saurus have set up has been affectionately known as the "Shinkansen Run" because of its Japanese origins and its rapid pace...2025-05-1236 min the fahrenheit performance podcastepisode 71 : japanese secret special sauceWe welcomed Kayato Ukai, a Japanese triathlete who loves to push the limits to the red seats this week.Originally from Kawanishi 川西市, in Hyogo prefecture, Japan, Kayato moved to Singapore to bring the supplement brand SAURUS to SE Asia. In a short few months he has made is presence felt personally by his great performances in the local endurance scene and also professionally but opening the door for the brand by establishing locally. The fortnightly run club that Kayato and Saurus have set up has been affectionately known as the "Shinkansen Run" because of its Japanese origins and its rapid...2025-05-1236 min
the fahrenheit performance podcastepisode 71 : japanese secret special sauceWe welcomed Kayato Ukai, a Japanese triathlete who loves to push the limits to the red seats this week.Originally from Kawanishi 川西市, in Hyogo prefecture, Japan, Kayato moved to Singapore to bring the supplement brand SAURUS to SE Asia. In a short few months he has made is presence felt personally by his great performances in the local endurance scene and also professionally but opening the door for the brand by establishing locally. The fortnightly run club that Kayato and Saurus have set up has been affectionately known as the "Shinkansen Run" because of its Japanese origins and its rapid...2025-05-1236 min Realm NewsRealm News Presents: An Exclusive Interview with the Minecraft Bloc TeamIn Episode 69 of Realm News, host Greg Howard, a.k.a. The Dark Lord, takes listeners on a captivating journey into the intersection of Minecraft and academia. Join Greg as he interviews three accomplished scholars from Concordia University’s Milieux Institute for Arts, Culture and Technology, exploring their innovative research conducted within the virtual realms of Minecraft. Discover how the Minecraft Bloc Team leverages Minecraft as a powerful tool for scholarly investigation, and learn about their groundbreaking project, SunBloc One. Delve into the project's mission to harness solar energy and rethink gaming's environmental impact, while uncovering the uni...2025-04-241h 23
Realm NewsRealm News Presents: An Exclusive Interview with the Minecraft Bloc TeamIn Episode 69 of Realm News, host Greg Howard, a.k.a. The Dark Lord, takes listeners on a captivating journey into the intersection of Minecraft and academia. Join Greg as he interviews three accomplished scholars from Concordia University’s Milieux Institute for Arts, Culture and Technology, exploring their innovative research conducted within the virtual realms of Minecraft. Discover how the Minecraft Bloc Team leverages Minecraft as a powerful tool for scholarly investigation, and learn about their groundbreaking project, SunBloc One. Delve into the project's mission to harness solar energy and rethink gaming's environmental impact, while uncovering the uni...2025-04-241h 23 貴族な食事会#2 「手土産のはなし」第2回目は、「手土産のこと」についておしゃべりしました。選ぶのは楽しいけれど、何にするか悩むことも多い手土産。みなさんのお気に入りはなんですか? 今回は3人の手土産事情についてと、大好きな金沢のお土産についても語りました。---------------------------------------------------------------🍪今回登場したおいしいものたち・paul giraud(ポールジロー)- スパークリング グレープジュース・maison du miel - クッキー缶 https://www.instagram.com/la_maison_du_miel?igsh=MThseTVndjliM3dyYg==・Atelier UKAI(アトリエうかい)- ふきよせ夕暮れ https://www.ukai.co.jp/atelier_topics/lineup-cookie/・甘納豆かわむら https://mame-kawamura.com/・加賀麩 不室屋 - おやつ麩 https://www.fumuroya.co.jp/products/kanmi/・金沢うら田 - 愛香菓 https://urata-k-store.shop-pro.jp/?pid=139128245 ※諸江屋さんではなく、うら田さんのお菓子でした…・丸八製茶場 - 献上加賀棒茶 https://kagaboucha.com/・和菓子村上 - 垣穂 https://www.wagashi-murakami.com/products/detail/136---------------------------------------------------------------🕰️Podcast毎週月曜日18時配信予定🍷Instagramエピソードにまつわる写真や過去の写真を更2024-11-2523 min
貴族な食事会#2 「手土産のはなし」第2回目は、「手土産のこと」についておしゃべりしました。選ぶのは楽しいけれど、何にするか悩むことも多い手土産。みなさんのお気に入りはなんですか? 今回は3人の手土産事情についてと、大好きな金沢のお土産についても語りました。---------------------------------------------------------------🍪今回登場したおいしいものたち・paul giraud(ポールジロー)- スパークリング グレープジュース・maison du miel - クッキー缶 https://www.instagram.com/la_maison_du_miel?igsh=MThseTVndjliM3dyYg==・Atelier UKAI(アトリエうかい)- ふきよせ夕暮れ https://www.ukai.co.jp/atelier_topics/lineup-cookie/・甘納豆かわむら https://mame-kawamura.com/・加賀麩 不室屋 - おやつ麩 https://www.fumuroya.co.jp/products/kanmi/・金沢うら田 - 愛香菓 https://urata-k-store.shop-pro.jp/?pid=139128245 ※諸江屋さんではなく、うら田さんのお菓子でした…・丸八製茶場 - 献上加賀棒茶 https://kagaboucha.com/・和菓子村上 - 垣穂 https://www.wagashi-murakami.com/products/detail/136---------------------------------------------------------------🕰️Podcast毎週月曜日18時配信予定🍷Instagramエピソードにまつわる写真や過去の写真を更2024-11-2523 min Local DisturbancesLocal Disturbances - Shorts #38 - The Problem with AI EthicsIn this episode, we explore the complex and often contentious relationship between ethics and artificial intelligence, delving into how human experiences and ethical judgments are shaped by our diverse backgrounds and perspectives. Through a thought-provoking discussion on public expressions, institutional control, and the growing field of AI ethics, we question whether AI might be amplifying existing power structures or offering a chance for disruption. Reflecting on Western institutional frameworks, the role of nation-states, and the challenges of meaning-making, we ask: What are we forfeiting by relying on external authorities to define good and bad? And what opportunities might emerge as...2024-10-0311 min
Local DisturbancesLocal Disturbances - Shorts #38 - The Problem with AI EthicsIn this episode, we explore the complex and often contentious relationship between ethics and artificial intelligence, delving into how human experiences and ethical judgments are shaped by our diverse backgrounds and perspectives. Through a thought-provoking discussion on public expressions, institutional control, and the growing field of AI ethics, we question whether AI might be amplifying existing power structures or offering a chance for disruption. Reflecting on Western institutional frameworks, the role of nation-states, and the challenges of meaning-making, we ask: What are we forfeiting by relying on external authorities to define good and bad? And what opportunities might emerge as...2024-10-0311 min Local DisturbancesLocal Disturbances - Shorts #37 - Final Notes on Double Voiced SpeechIn this episode, we delve into the complex interplay between synthetic language and ideological structures, exploring how creative applications of generative language can destabilize and reinterpret existing norms. We discuss the role of stylization as both an artistic necessity and a subtle form of protest, drawing on insights from Albert Camus and Terry Eagleton. The episode also touches on the concept of double-voiced speech, where mimicking established forms of communication allows for subversive reinterpretation, particularly in environments where open dissent is risky.
We examine the nuances of confounded authorship, where the interaction between human prompts and AI-generated responses creates a...2024-08-2809 min
Local DisturbancesLocal Disturbances - Shorts #37 - Final Notes on Double Voiced SpeechIn this episode, we delve into the complex interplay between synthetic language and ideological structures, exploring how creative applications of generative language can destabilize and reinterpret existing norms. We discuss the role of stylization as both an artistic necessity and a subtle form of protest, drawing on insights from Albert Camus and Terry Eagleton. The episode also touches on the concept of double-voiced speech, where mimicking established forms of communication allows for subversive reinterpretation, particularly in environments where open dissent is risky.
We examine the nuances of confounded authorship, where the interaction between human prompts and AI-generated responses creates a...2024-08-2809 min Local DisturbancesLocal Disturbances - Shorts #2 - How can we feel AI?This episode of "Local Disturbances: Shorts" addresses the need for a deeper and more nuanced discussion about artificial intelligence (AI) and its impact on human culture and the natural world. The podcast emphasizes the importance of exploring and critiquing AI systems in order to avoid the negative aspects of our current society, particularly those driven by a fixation on efficiency and growth. It highlights the distinction between general knowledge of AI as a concept and the specific, localized experiences of living with AI's effects.
The discussion also touches on the necessity of moving away from Western-centric perspectives in understanding AI...2024-08-2110 min
Local DisturbancesLocal Disturbances - Shorts #2 - How can we feel AI?This episode of "Local Disturbances: Shorts" addresses the need for a deeper and more nuanced discussion about artificial intelligence (AI) and its impact on human culture and the natural world. The podcast emphasizes the importance of exploring and critiquing AI systems in order to avoid the negative aspects of our current society, particularly those driven by a fixation on efficiency and growth. It highlights the distinction between general knowledge of AI as a concept and the specific, localized experiences of living with AI's effects.
The discussion also touches on the necessity of moving away from Western-centric perspectives in understanding AI...2024-08-2110 min Local DisturbancesLocal Disturbances - Shorts #36 - Generative Language as a Vehicle for SatireIn this episode, we explore the intriguing intersection of satire and AI-generated language, delving into how synthetic language can serve as both a mask and a vehicle for subversive humor. We examine the historical role of satire in challenging societal norms and power structures, and how this tradition can be extended into the digital age using generative AI. By discussing concepts from Bakhtin’s theory of the carnivalesque to modern examples like the AI-generated entity Loab, we invite listeners to consider the potential of AI as a tool for cultural commentary and critique.
Words by Jerrold McGrath
Production and Sound by...2024-08-2118 min
Local DisturbancesLocal Disturbances - Shorts #36 - Generative Language as a Vehicle for SatireIn this episode, we explore the intriguing intersection of satire and AI-generated language, delving into how synthetic language can serve as both a mask and a vehicle for subversive humor. We examine the historical role of satire in challenging societal norms and power structures, and how this tradition can be extended into the digital age using generative AI. By discussing concepts from Bakhtin’s theory of the carnivalesque to modern examples like the AI-generated entity Loab, we invite listeners to consider the potential of AI as a tool for cultural commentary and critique.
Words by Jerrold McGrath
Production and Sound by...2024-08-2118 min Local DisturbancesLocal Disturbances - Shorts #3 - AI and Land, Body, and DiasporaThis episode from "Local Disturbances: Shorts" discusses our collaborative program on Algorithmic Culture, led by the Goethe-Institut Toronto. The initiative focused on fostering creative and artistic engagements with artificial intelligence (AI). It involved networking, workshops, and the production of artist ‘zines, emphasizing a local, idiosyncratic approach to engage and educate communities about AI.
Key themes explored include the impact of AI on our perception and interaction with our bodies, intimacy, land, stewardship, and diaspora. The program examined how algorithmic culture influences our understanding of these elements and their interconnections. It highlighted issues like facial recognition systems' biases and the need fo...2024-08-2109 min
Local DisturbancesLocal Disturbances - Shorts #3 - AI and Land, Body, and DiasporaThis episode from "Local Disturbances: Shorts" discusses our collaborative program on Algorithmic Culture, led by the Goethe-Institut Toronto. The initiative focused on fostering creative and artistic engagements with artificial intelligence (AI). It involved networking, workshops, and the production of artist ‘zines, emphasizing a local, idiosyncratic approach to engage and educate communities about AI.
Key themes explored include the impact of AI on our perception and interaction with our bodies, intimacy, land, stewardship, and diaspora. The program examined how algorithmic culture influences our understanding of these elements and their interconnections. It highlighted issues like facial recognition systems' biases and the need fo...2024-08-2109 min Local DisturbancesLocal Disturbances - Shorts #1 - What is Algorithmic Culture?Shorts are brief introductions to ideas we are exploring at UKAI Projects.
What is Algorithmic Culture? explores the profound impact of AI and algorithms on modern life. Historically, algorithms were human-readable, but they've evolved beyond human comprehension due to data complexity and system intricacies. Advances in machine learning and data collection have accelerated this evolution, leading to algorithms that govern our lives in ways we can't fully understand or control.
The podcast highlights the dual nature of this progression: while algorithmic solutions promise efficiency and growth, they also risk exacerbating systemic inequalities and biases. The increasing reliance on AI raises...2024-08-2110 min
Local DisturbancesLocal Disturbances - Shorts #1 - What is Algorithmic Culture?Shorts are brief introductions to ideas we are exploring at UKAI Projects.
What is Algorithmic Culture? explores the profound impact of AI and algorithms on modern life. Historically, algorithms were human-readable, but they've evolved beyond human comprehension due to data complexity and system intricacies. Advances in machine learning and data collection have accelerated this evolution, leading to algorithms that govern our lives in ways we can't fully understand or control.
The podcast highlights the dual nature of this progression: while algorithmic solutions promise efficiency and growth, they also risk exacerbating systemic inequalities and biases. The increasing reliance on AI raises...2024-08-2110 min Local DisturbancesLocal Disturbances - Shorts 35 - Critique in the Arts: Point vs. SystemIn this episode, we explore the potential for AI to either centralize or decentralize control in decision-making processes within the arts. We discuss how AI's ability to separate prediction from judgment could reduce reliance on rigid institutional structures and promote individual decision-making. The conversation delves into how institutions manage complexity and how AI might disrupt these mechanisms. We distinguish between 'point solutions' and 'systemic solutions' in AI applications, examining their implications for the arts and questioning the role of class interests in critiques of AI. The episode concludes by contemplating the broader societal changes AI could bring to the arts...2024-06-1410 min
Local DisturbancesLocal Disturbances - Shorts 35 - Critique in the Arts: Point vs. SystemIn this episode, we explore the potential for AI to either centralize or decentralize control in decision-making processes within the arts. We discuss how AI's ability to separate prediction from judgment could reduce reliance on rigid institutional structures and promote individual decision-making. The conversation delves into how institutions manage complexity and how AI might disrupt these mechanisms. We distinguish between 'point solutions' and 'systemic solutions' in AI applications, examining their implications for the arts and questioning the role of class interests in critiques of AI. The episode concludes by contemplating the broader societal changes AI could bring to the arts...2024-06-1410 min Local DisturbancesLocal Disturbances - Shorts #34 - Talking With and Through Generative TextIn this episode of Local Disturbances, we delve into the intricate world of generative text and its place in prose art. Drawing inspiration from Mikhail Bakhtin's concept of "artistically representing language," we explore how different genres and styles of language interact within a novel to create a dynamic and ever-evolving narrative.
Our discussion focuses on the dialogic nature of language in literature, examining how authors use familiar forms like love letters to engage readers on multiple levels. We consider the historical and cultural contexts that shape readers' interpretations, emphasizing how contemporary readers bring new perspectives to traditional forms.
Moving to...2024-06-0308 min
Local DisturbancesLocal Disturbances - Shorts #34 - Talking With and Through Generative TextIn this episode of Local Disturbances, we delve into the intricate world of generative text and its place in prose art. Drawing inspiration from Mikhail Bakhtin's concept of "artistically representing language," we explore how different genres and styles of language interact within a novel to create a dynamic and ever-evolving narrative.
Our discussion focuses on the dialogic nature of language in literature, examining how authors use familiar forms like love letters to engage readers on multiple levels. We consider the historical and cultural contexts that shape readers' interpretations, emphasizing how contemporary readers bring new perspectives to traditional forms.
Moving to...2024-06-0308 min Raysean Gadson Anime Podcast[S4] Episode 80 (Behind the Mic: with David Wald - Voice of Askeladd, Snipe, Vetto, Keishin Ukai, and Gajeel Redfox)Hey, anime fans! It’s your boy Raysean from the Raysean Gadson Anime Podcast, or R-GAP for short. In today's special episode, we’re joined by David Wald, the voice actor behind Askeladd in Vinland Saga, Snipe in My Hero Academia, Vetto in Black Clover, Keishin Ukai in Haikyu!, and Gajeel Redfox in Fairy Tail. We'll be diving into his experiences in voice acting, exploring his personal life, and sharing tips on breaking into the industry. If this sparks your interest, sit back and enjoy the ride. Don't forget to like and subscribe wherever you're listening! Also, be sure to c...2024-05-281h 30
Raysean Gadson Anime Podcast[S4] Episode 80 (Behind the Mic: with David Wald - Voice of Askeladd, Snipe, Vetto, Keishin Ukai, and Gajeel Redfox)Hey, anime fans! It’s your boy Raysean from the Raysean Gadson Anime Podcast, or R-GAP for short. In today's special episode, we’re joined by David Wald, the voice actor behind Askeladd in Vinland Saga, Snipe in My Hero Academia, Vetto in Black Clover, Keishin Ukai in Haikyu!, and Gajeel Redfox in Fairy Tail. We'll be diving into his experiences in voice acting, exploring his personal life, and sharing tips on breaking into the industry. If this sparks your interest, sit back and enjoy the ride. Don't forget to like and subscribe wherever you're listening! Also, be sure to c...2024-05-281h 30 Local DisturbancesLocal Disturbances - Shorts #33 - Erotic Fiction: Generative AI and AlterityIn this episode of "Local Disturbances" we delve into the nuanced intersections of generative AI, erotic fiction, and the concept of alterity. Drawing on insights from Byung Chul Han and Mikhail Bakhtin, we explore the pervasive feeling of loneliness in AI-generated content and its implications for our understanding of the "Other." This absence of alterity in digital creations, where texts and images lack the depth of human interaction, accelerates our cultural shift towards narcissism and diminishes our capacity for love and genuine engagement. We discuss how traditional notions of Otherness are being transformed by digital connectivity and self-exploitation, leading to...2024-05-2210 min
Local DisturbancesLocal Disturbances - Shorts #33 - Erotic Fiction: Generative AI and AlterityIn this episode of "Local Disturbances" we delve into the nuanced intersections of generative AI, erotic fiction, and the concept of alterity. Drawing on insights from Byung Chul Han and Mikhail Bakhtin, we explore the pervasive feeling of loneliness in AI-generated content and its implications for our understanding of the "Other." This absence of alterity in digital creations, where texts and images lack the depth of human interaction, accelerates our cultural shift towards narcissism and diminishes our capacity for love and genuine engagement. We discuss how traditional notions of Otherness are being transformed by digital connectivity and self-exploitation, leading to...2024-05-2210 min Local DisturbancesLocal Disturbances - Shorts #32 - With Generative Language, Nobody Knows You're a DogIn this episode, we continue to delve into the implications of generative language tools and their potential to reshape our world and our understanding of it. Drawing parallels to the transformative impact of the printing press, we explore how these modern innovations could similarly influence language, communication, and society.
We begin by reflecting on the historical context of the printing press and its role in standardizing languages, promoting literacy, and democratizing knowledge. However, this technological leap also faced criticism and concerns—echoing the current debates surrounding generative language models.
Our discussion navigates through various theoretical frameworks to understand the cultural tr...2024-05-1509 min
Local DisturbancesLocal Disturbances - Shorts #32 - With Generative Language, Nobody Knows You're a DogIn this episode, we continue to delve into the implications of generative language tools and their potential to reshape our world and our understanding of it. Drawing parallels to the transformative impact of the printing press, we explore how these modern innovations could similarly influence language, communication, and society.
We begin by reflecting on the historical context of the printing press and its role in standardizing languages, promoting literacy, and democratizing knowledge. However, this technological leap also faced criticism and concerns—echoing the current debates surrounding generative language models.
Our discussion navigates through various theoretical frameworks to understand the cultural tr...2024-05-1509 min Local DisturbancesLocal Disturbances - Shorts #31 - AI in the WildIn this episode of Local Disturbances titled "AI in the Wild," host Jerrold McGrath delves into the transformative potential of artificial intelligence (AI) in reshaping our interactions with the world. We explore the awe-inspiring capabilities of conversational agents like ChatGPT and GPT-4, which demonstrate an ability to mediate among various systems, thereby challenging institutional logics and expectations. Drawing inspiration from Ivan Illich's critique of institutionalized systems, we discuss how AI can enable personal autonomy and novel aesthetic experiences by decentralizing institutional control.
The episode highlights significant innovations, such as the creation of APIs based on large language models, allowing for...2024-05-1009 min
Local DisturbancesLocal Disturbances - Shorts #31 - AI in the WildIn this episode of Local Disturbances titled "AI in the Wild," host Jerrold McGrath delves into the transformative potential of artificial intelligence (AI) in reshaping our interactions with the world. We explore the awe-inspiring capabilities of conversational agents like ChatGPT and GPT-4, which demonstrate an ability to mediate among various systems, thereby challenging institutional logics and expectations. Drawing inspiration from Ivan Illich's critique of institutionalized systems, we discuss how AI can enable personal autonomy and novel aesthetic experiences by decentralizing institutional control.
The episode highlights significant innovations, such as the creation of APIs based on large language models, allowing for...2024-05-1009 min Local DisturbancesLocal Disturbances - Shorts #30 - Representing Algorithmic Systems (pt. 2)In this episode, we continue our exploration of approaches to representing algorithmic systems. Specifically, we draw on Mikhail Bakhtin's ideas of novelization as a means of perceiving and working with AI in artistic creation.
Two specific initiatives are referenced as inspirations in this work: Forensic Architecture and the Hart Island Project.
Sound by Koohyar Habibi
Produced by Kasra Goodarznezhad
Words by Jerrold McGrath2024-04-2908 min
Local DisturbancesLocal Disturbances - Shorts #30 - Representing Algorithmic Systems (pt. 2)In this episode, we continue our exploration of approaches to representing algorithmic systems. Specifically, we draw on Mikhail Bakhtin's ideas of novelization as a means of perceiving and working with AI in artistic creation.
Two specific initiatives are referenced as inspirations in this work: Forensic Architecture and the Hart Island Project.
Sound by Koohyar Habibi
Produced by Kasra Goodarznezhad
Words by Jerrold McGrath2024-04-2908 min Local DisturbancesLocal Disturbances - Shorts #29 - Representing Algorithmic Systems (pt. 1)In this episode, we dive deep into the exploration of sociotechnical systems through creative and novelistic approaches.
We reflect on the various invisible and visible forces that shape our perceptions and interactions with the world, touching on themes from Fernando Pessoa’s critique of social fictions to C. Thi Nguyen's concept of "agential distance," which examines the constraints imposed on us by societal systems. The episode also addresses the impact of algorithmic systems, like automated cash registers and transit systems, on our daily lives and social interactions, showcasing both the advantages and the isolating effects of these technologies.
A significant po...2024-04-2209 min
Local DisturbancesLocal Disturbances - Shorts #29 - Representing Algorithmic Systems (pt. 1)In this episode, we dive deep into the exploration of sociotechnical systems through creative and novelistic approaches.
We reflect on the various invisible and visible forces that shape our perceptions and interactions with the world, touching on themes from Fernando Pessoa’s critique of social fictions to C. Thi Nguyen's concept of "agential distance," which examines the constraints imposed on us by societal systems. The episode also addresses the impact of algorithmic systems, like automated cash registers and transit systems, on our daily lives and social interactions, showcasing both the advantages and the isolating effects of these technologies.
A significant po...2024-04-2209 min Local DisturbancesLocal Disturbances - Shorts #28 - In Praise of DisorderIn this episode of Local Disturbances, author Jerrold McGrath delves into the themes and personal experiences surrounding his book, "In Praise of Disorder." Jerrold shares the anxiety and relief of publishing a book that took three years to complete, discussing the inspiration behind the 256-page work and his collaboration with artist Nour Bishouty and editor Richard Martin. He reflects on his decision to avoid mainstream publishing routes, highlighting the book’s critique of artificial intelligence and modern society’s obsession with order. The episode further explores Jerry's thoughts on cultural continuity, as influenced by thinkers like José Ortega y Gasset and I...2024-04-1506 min
Local DisturbancesLocal Disturbances - Shorts #28 - In Praise of DisorderIn this episode of Local Disturbances, author Jerrold McGrath delves into the themes and personal experiences surrounding his book, "In Praise of Disorder." Jerrold shares the anxiety and relief of publishing a book that took three years to complete, discussing the inspiration behind the 256-page work and his collaboration with artist Nour Bishouty and editor Richard Martin. He reflects on his decision to avoid mainstream publishing routes, highlighting the book’s critique of artificial intelligence and modern society’s obsession with order. The episode further explores Jerry's thoughts on cultural continuity, as influenced by thinkers like José Ortega y Gasset and I...2024-04-1506 min Local DisturbancesLocal Disturbances - Shorts #27 - The Subsoil of ThoughtIn this episode of Local Disturbances we delve into the complexities of AI development, language modelling, and the exploration of different historical and cultural perspectives. The team at UKAI is pushing the boundaries by attempting to train AI bots on specific historical periods, aiming to bridge the gap between literature, culture, and AI.
Our focus lies on the transition from Medieval to Renaissance thought in 16th century Western Europe, a pivotal period that birthed the modern novel. By training language models on this narrow cosmology, we hoped to offer audiences a unique window into historical ways of knowing the world.
...2024-04-0811 min
Local DisturbancesLocal Disturbances - Shorts #27 - The Subsoil of ThoughtIn this episode of Local Disturbances we delve into the complexities of AI development, language modelling, and the exploration of different historical and cultural perspectives. The team at UKAI is pushing the boundaries by attempting to train AI bots on specific historical periods, aiming to bridge the gap between literature, culture, and AI.
Our focus lies on the transition from Medieval to Renaissance thought in 16th century Western Europe, a pivotal period that birthed the modern novel. By training language models on this narrow cosmology, we hoped to offer audiences a unique window into historical ways of knowing the world.
...2024-04-0811 min Local DisturbancesLocal Disturbances - Shorts #26 - Fake Plastic TreesIn this episode, we delve into the ubiquitous presence of plastic in our lives, tracing its explosive growth from the mid-20th century and examining its profound impact on both human and ecological health. We reflect on the staggering production of plastic, its role in shaping modern lifestyles, and the emerging concerns over its long-term effects. Transitioning from the tangible to the intangible, the discussion shifts to the advent of synthetic language and its parallels with the proliferation of plastic. We explore the cultural and artistic ramifications of large language models like ChatGPT, pondering the future of language, communication, and...2024-04-0309 min
Local DisturbancesLocal Disturbances - Shorts #26 - Fake Plastic TreesIn this episode, we delve into the ubiquitous presence of plastic in our lives, tracing its explosive growth from the mid-20th century and examining its profound impact on both human and ecological health. We reflect on the staggering production of plastic, its role in shaping modern lifestyles, and the emerging concerns over its long-term effects. Transitioning from the tangible to the intangible, the discussion shifts to the advent of synthetic language and its parallels with the proliferation of plastic. We explore the cultural and artistic ramifications of large language models like ChatGPT, pondering the future of language, communication, and...2024-04-0309 min Local DisturbancesLocal Disturbances - Shorts #25 - The Trouble with Synthetic LanguageIn this episode, we delve deep into the complexities of language and artificial intelligence, exploring themes that challenge our conventional approaches to AI development. At a time when large language models like ChatGPT and GPT-4 are under the spotlight, we address the contentious debate surrounding digital art generated from natural language prompts, urging for a more nuanced dialogue that transcends the polarizing platforms hosting these discussions.
We spotlight an insightful article by Benjamin Bratton and Blaise Agüera y Arcas in Noema, advocating for the development of new languages to navigate the philosophy of artificial intelligence. This call for a r...2024-03-2509 min
Local DisturbancesLocal Disturbances - Shorts #25 - The Trouble with Synthetic LanguageIn this episode, we delve deep into the complexities of language and artificial intelligence, exploring themes that challenge our conventional approaches to AI development. At a time when large language models like ChatGPT and GPT-4 are under the spotlight, we address the contentious debate surrounding digital art generated from natural language prompts, urging for a more nuanced dialogue that transcends the polarizing platforms hosting these discussions.
We spotlight an insightful article by Benjamin Bratton and Blaise Agüera y Arcas in Noema, advocating for the development of new languages to navigate the philosophy of artificial intelligence. This call for a r...2024-03-2509 min Local DisturbancesLocal Disturbances - Shorts #24 - The Arts has a FeverIn this episode of Local Disturbances, we delve into the experiences and insights gained from our recent visit to the UK in December of 2022. We discuss our participation in various activities, including a talk at the University of the Arts London, meetings, and notably, a workshop for our Restructuring Futures project. This project, developed in partnership with the Laboratory for Artistic Intelligence and Hypha Engineering Co-op, focuses on building infrastructure for creative and cultural collaboration that can withstand volatile conditions, such as climate change and rising authoritarianism. Our time in London also included a meaningful engagement in artist paula roush's...2024-03-2009 min
Local DisturbancesLocal Disturbances - Shorts #24 - The Arts has a FeverIn this episode of Local Disturbances, we delve into the experiences and insights gained from our recent visit to the UK in December of 2022. We discuss our participation in various activities, including a talk at the University of the Arts London, meetings, and notably, a workshop for our Restructuring Futures project. This project, developed in partnership with the Laboratory for Artistic Intelligence and Hypha Engineering Co-op, focuses on building infrastructure for creative and cultural collaboration that can withstand volatile conditions, such as climate change and rising authoritarianism. Our time in London also included a meaningful engagement in artist paula roush's...2024-03-2009 min Local DisturbancesLocal Disturbances - Shorts #23 - Please Don't Understand ThisIn this episode, we delve into the complexities of language evolution, the impact of hegemonic language in culture, and the unique ways communities around the globe respond to and contest these norms through the creation of new forms of language and symbols. Highlighting the dynamic nature of language, we explore the creation of coded communication by migrant workers in the early 20th century and question what modern equivalents might exist today. The episode further examines the dominance of Western ideas of rationality, especially in discussions around AI and its ethical implications, suggesting a narrow interpretation of reality and meaning.
We...2024-03-1109 min
Local DisturbancesLocal Disturbances - Shorts #23 - Please Don't Understand ThisIn this episode, we delve into the complexities of language evolution, the impact of hegemonic language in culture, and the unique ways communities around the globe respond to and contest these norms through the creation of new forms of language and symbols. Highlighting the dynamic nature of language, we explore the creation of coded communication by migrant workers in the early 20th century and question what modern equivalents might exist today. The episode further examines the dominance of Western ideas of rationality, especially in discussions around AI and its ethical implications, suggesting a narrow interpretation of reality and meaning.
We...2024-03-1109 min Local DisturbancesLocal Disturbances - Shorts #22 - Local DisturbancesIn this episode of "Local Disturbances," the team delves into the complexities of navigating our rapidly changing social and cultural landscapes, marked by the rise of automated and algorithmic systems. Amidst their own anxieties about broadcasting half-formed thoughts to a growing audience, we explore the profound alterations in our interaction with the environment and each other, driven by technological advancements and capitalist demands. The episode critically examines how the erosion of language and knowledge connected to natural landscapes parallels the challenges we face in articulating and responding to the invisible terrains shaped by AI and algorithms. Through a thoughtful investigation...2024-03-0106 min
Local DisturbancesLocal Disturbances - Shorts #22 - Local DisturbancesIn this episode of "Local Disturbances," the team delves into the complexities of navigating our rapidly changing social and cultural landscapes, marked by the rise of automated and algorithmic systems. Amidst their own anxieties about broadcasting half-formed thoughts to a growing audience, we explore the profound alterations in our interaction with the environment and each other, driven by technological advancements and capitalist demands. The episode critically examines how the erosion of language and knowledge connected to natural landscapes parallels the challenges we face in articulating and responding to the invisible terrains shaped by AI and algorithms. Through a thoughtful investigation...2024-03-0106 min Local DisturbancesLocal Disturbances - Shorts #21 - Disciplined by IdeologyIn this episode, we recount the experiences and insights gained from the Ferment AI residency, a year-long project involving nine artists exploring artificial intelligence and cognitive technologies in their creative practices. The episode reflects on various events, including a showcase in Berlin attended by approximately 100 people, featuring works in progress, a live performance, and impromptu food and drink arrangements due to a last-minute cancellation by our caterer.
We delve into the residency's participation in the AI Anarchies Autumn school at the Akademie der Künste, highlighting the critical perspectives on technology's trajectory and the emphasis on reimagining AI ethics through d...2024-02-2110 min
Local DisturbancesLocal Disturbances - Shorts #21 - Disciplined by IdeologyIn this episode, we recount the experiences and insights gained from the Ferment AI residency, a year-long project involving nine artists exploring artificial intelligence and cognitive technologies in their creative practices. The episode reflects on various events, including a showcase in Berlin attended by approximately 100 people, featuring works in progress, a live performance, and impromptu food and drink arrangements due to a last-minute cancellation by our caterer.
We delve into the residency's participation in the AI Anarchies Autumn school at the Akademie der Künste, highlighting the critical perspectives on technology's trajectory and the emphasis on reimagining AI ethics through d...2024-02-2110 min Local DisturbancesLocal Disturbances - Shorts #20 - The Computer is Your RedactedIn this episode, we introduce a unique audio play that merges artificial intelligence discourse with the world of tabletop role-playing games. The podcast, stemming from a project initiated in 2022 and seeking further development in 2023, features a diverse group of experts—a business leader, an artist, an ethicist, and an academic—playing a modified version of the 1980s classic game Paranoia! in an audio series format. This creative endeavor was produced as part of the Goethe-Institut Toronto's Algorithmic Culture programming and aims to explore collective anxieties about automation and AI in a fun, engaging, and unorthodox manner.
The choice of Paranoia!, a ga...2024-02-1206 min
Local DisturbancesLocal Disturbances - Shorts #20 - The Computer is Your RedactedIn this episode, we introduce a unique audio play that merges artificial intelligence discourse with the world of tabletop role-playing games. The podcast, stemming from a project initiated in 2022 and seeking further development in 2023, features a diverse group of experts—a business leader, an artist, an ethicist, and an academic—playing a modified version of the 1980s classic game Paranoia! in an audio series format. This creative endeavor was produced as part of the Goethe-Institut Toronto's Algorithmic Culture programming and aims to explore collective anxieties about automation and AI in a fun, engaging, and unorthodox manner.
The choice of Paranoia!, a ga...2024-02-1206 min Local DisturbancesLocal Disturbances - Shorts #19 - AI RitualsToday's episode discusses an interactive art project presented by UKAI Projects at the Hebbel am Ufer (HAU) theatre in Berlin during the Spy on Me Festival #4. This event was part of STO Union's takeover of the venue. The project involved inviting audience members to share their hopes and fears with an AI on stage, which would then project these emotions onto giant screens for everyone to see. The responses also prompted a language model to generate its own responses, which were broadcast in the theatre before being deleted, allowing a new cycle to begin.
The AI, developed through UKAI Projects...2024-02-0906 min
Local DisturbancesLocal Disturbances - Shorts #19 - AI RitualsToday's episode discusses an interactive art project presented by UKAI Projects at the Hebbel am Ufer (HAU) theatre in Berlin during the Spy on Me Festival #4. This event was part of STO Union's takeover of the venue. The project involved inviting audience members to share their hopes and fears with an AI on stage, which would then project these emotions onto giant screens for everyone to see. The responses also prompted a language model to generate its own responses, which were broadcast in the theatre before being deleted, allowing a new cycle to begin.
The AI, developed through UKAI Projects...2024-02-0906 min Local DisturbancesLocal Disturbances - Shorts #18 - Not Every Story Needs a VillainThis episode explores the impact of algorithmic technologies on culture production and appreciation, emphasizing the need for a nuanced understanding beyond binary categorizations of good and evil. It draws an analogy with the Japanese practice of 'ukai' to illustrate how categorizing experiences can limit understanding, similar to the limitations imposed by algorithmic systems.
The episode critiques the polarized discourse often found in discussions about big data and surveillance, where narratives are simplified into heroes and villains. The speaker, Jerrold McGrath, argues for the introduction of ambiguity and wonder into our encounters with these technologies, challenging the reduction of complex issues...2024-02-0707 min
Local DisturbancesLocal Disturbances - Shorts #18 - Not Every Story Needs a VillainThis episode explores the impact of algorithmic technologies on culture production and appreciation, emphasizing the need for a nuanced understanding beyond binary categorizations of good and evil. It draws an analogy with the Japanese practice of 'ukai' to illustrate how categorizing experiences can limit understanding, similar to the limitations imposed by algorithmic systems.
The episode critiques the polarized discourse often found in discussions about big data and surveillance, where narratives are simplified into heroes and villains. The speaker, Jerrold McGrath, argues for the introduction of ambiguity and wonder into our encounters with these technologies, challenging the reduction of complex issues...2024-02-0707 min Local DisturbancesLocal Disturbances - Shorts #17 - Uncovering AIMost AI is being developed with the values of growth and efficiency (scale) in mind. Things are designed to go faster and bigger. Even in more ‘socially minded’ solutions, the intent is overwhelmingly to optimize otherwise scarce resources. Other values — such as love, community, compassion, or autonomy — are being marginalized or excluded outright through both the technical design of systems and the institutions that determine the direction of development. We are seeking to increase access to algorithmic tools and techniques so that other values and moral positions can benefit from these advances. We also seek to interrogate the hegemony of scale as...2024-02-0507 min
Local DisturbancesLocal Disturbances - Shorts #17 - Uncovering AIMost AI is being developed with the values of growth and efficiency (scale) in mind. Things are designed to go faster and bigger. Even in more ‘socially minded’ solutions, the intent is overwhelmingly to optimize otherwise scarce resources. Other values — such as love, community, compassion, or autonomy — are being marginalized or excluded outright through both the technical design of systems and the institutions that determine the direction of development. We are seeking to increase access to algorithmic tools and techniques so that other values and moral positions can benefit from these advances. We also seek to interrogate the hegemony of scale as...2024-02-0507 min Local DisturbancesLocal Disturbances - Shorts #16 - AI with Chinese CharacteristicsIn this episode, we explore the impact of the war on individuals and the ongoing pattern of "mobilized mistrust" in international relations, particularly in the context of the rise of China and nationalism. We look at the similarities in AI development between China and Western nations, cautioning against conflating governmental actions with the sentiments of the general population. We highlight the growing anti-Chinese sentiment in Canada, exacerbated by COVID-19, and warn against the dangers of 'othering'.
China's significant advancements in AI are acknowledged, and we advocate for mutual learning and collaboration between nations. We reference David Graeber and David Wingrow's...2024-02-0208 min
Local DisturbancesLocal Disturbances - Shorts #16 - AI with Chinese CharacteristicsIn this episode, we explore the impact of the war on individuals and the ongoing pattern of "mobilized mistrust" in international relations, particularly in the context of the rise of China and nationalism. We look at the similarities in AI development between China and Western nations, cautioning against conflating governmental actions with the sentiments of the general population. We highlight the growing anti-Chinese sentiment in Canada, exacerbated by COVID-19, and warn against the dangers of 'othering'.
China's significant advancements in AI are acknowledged, and we advocate for mutual learning and collaboration between nations. We reference David Graeber and David Wingrow's...2024-02-0208 min Local DisturbancesLocal Disturbances - Shorts #15 - Evolution of Artistic Forms with AIThis short discusses the impact and potential of artificial intelligence (AI) on creative fields and storytelling. It begins with an analogy to the early days of television, where cameras simply captured radio broadcasts, highlighting how new technologies often start by mimicking existing forms before finding their unique applications.
The speaker notes that AI has predominantly been used for solving problems identified by legacy institutions, like corporations and governments, focusing on efficiency, growth, and administrative tasks. However, AI's potential in artistic and creative endeavors is vast and largely untapped. The episode suggests that the artistic forms that will thrive with AI...2024-01-1506 min
Local DisturbancesLocal Disturbances - Shorts #15 - Evolution of Artistic Forms with AIThis short discusses the impact and potential of artificial intelligence (AI) on creative fields and storytelling. It begins with an analogy to the early days of television, where cameras simply captured radio broadcasts, highlighting how new technologies often start by mimicking existing forms before finding their unique applications.
The speaker notes that AI has predominantly been used for solving problems identified by legacy institutions, like corporations and governments, focusing on efficiency, growth, and administrative tasks. However, AI's potential in artistic and creative endeavors is vast and largely untapped. The episode suggests that the artistic forms that will thrive with AI...2024-01-1506 min Local DisturbancesLocal Disturbances - Shorts #14 - AI Gatekeepers and the State of the ArtThis short reflects on the journey of UKAI Projects, who are not AI experts, into the world of AI and art. They initially engaged with this field through a partnership with the AI Impact Alliance and Akoulina Connell, leading to the delivery of workshops across Canada.
The speakers express a discomfort with being forced into "official" ideologies and see AI as amplifying these at the expense of alternative perspectives. They critique the binary viewpoints often presented in discussions about AI, arguing for a more nuanced and diverse understanding of the technology.
A talk by Noah Levenson in 2021 had a significant...2024-01-1507 min
Local DisturbancesLocal Disturbances - Shorts #14 - AI Gatekeepers and the State of the ArtThis short reflects on the journey of UKAI Projects, who are not AI experts, into the world of AI and art. They initially engaged with this field through a partnership with the AI Impact Alliance and Akoulina Connell, leading to the delivery of workshops across Canada.
The speakers express a discomfort with being forced into "official" ideologies and see AI as amplifying these at the expense of alternative perspectives. They critique the binary viewpoints often presented in discussions about AI, arguing for a more nuanced and diverse understanding of the technology.
A talk by Noah Levenson in 2021 had a significant...2024-01-1507 min Local DisturbancesLocal Disturbances - Shorts #13 - Unofficial WorldsThis short explores the intersection of artificial intelligence (AI) and art, emphasizing the need for art that challenges and diverges from "official" ideologies amplified by AI. It discusses the historical context of art as a means to question and reimagine societal norms, drawing inspiration from the concept of carnival as described by Mikhail Bakhtin.
Bakhtin's idea of the carnivalesque is central to the discussion. In historical carnivals, societal rules were temporarily suspended, hierarchies inverted, and the grotesque celebrated. These events allowed for liberation from established orders and hierarchies, fostering renewal and change. The newsletter suggests that modern equivalents like Burning...2024-01-1509 min
Local DisturbancesLocal Disturbances - Shorts #13 - Unofficial WorldsThis short explores the intersection of artificial intelligence (AI) and art, emphasizing the need for art that challenges and diverges from "official" ideologies amplified by AI. It discusses the historical context of art as a means to question and reimagine societal norms, drawing inspiration from the concept of carnival as described by Mikhail Bakhtin.
Bakhtin's idea of the carnivalesque is central to the discussion. In historical carnivals, societal rules were temporarily suspended, hierarchies inverted, and the grotesque celebrated. These events allowed for liberation from established orders and hierarchies, fostering renewal and change. The newsletter suggests that modern equivalents like Burning...2024-01-1509 min Local DisturbancesLocal Disturbances - Shorts #12 - Make it Weirder"Episode 12: Make it Weirder" from "Local Disturbances: Shorts" discusses the role of creativity, particularly through the concept of 'play', in the context of artificial intelligence and cultural dynamics. The episode reflects on the importance of decentralizing power and fostering local solutions, guided by autonomy and moral virtue, especially in the face of challenges like COVID-19, climate change, and inequality.
The narrative critiques the tendency to rely on machines for decision-making due to a feeling of inadequacy in facing collective challenges. It emphasizes the need for diverse viewpoints and the value of conversations, even when they are difficult.
Ferment AI, a...2024-01-0808 min
Local DisturbancesLocal Disturbances - Shorts #12 - Make it Weirder"Episode 12: Make it Weirder" from "Local Disturbances: Shorts" discusses the role of creativity, particularly through the concept of 'play', in the context of artificial intelligence and cultural dynamics. The episode reflects on the importance of decentralizing power and fostering local solutions, guided by autonomy and moral virtue, especially in the face of challenges like COVID-19, climate change, and inequality.
The narrative critiques the tendency to rely on machines for decision-making due to a feeling of inadequacy in facing collective challenges. It emphasizes the need for diverse viewpoints and the value of conversations, even when they are difficult.
Ferment AI, a...2024-01-0808 min Local DisturbancesLocal Disturbances - Shorts #11 - AI and the Construction of Meaning"Episode 11: AI and the Construction of Meaning" from "Local Disturbances: Shorts" explores the concept of meaning-making in human life and its contrast with artificial intelligence (AI). Drawing on Mikhail Bakhtin's philosophy, the episode delves into how humans construct meaning through their unique experiences, contexts, and subjective interpretations, a process Bakhtin refers to as "consummation."
The episode illustrates this with an example of two people experiencing a woman singing near a bus stop, highlighting how each individual's perspective and background inform their interpretation of the event. It argues that while humans are constantly assembling experiences into meaningful wholes, AI systems tend...2024-01-0808 min
Local DisturbancesLocal Disturbances - Shorts #11 - AI and the Construction of Meaning"Episode 11: AI and the Construction of Meaning" from "Local Disturbances: Shorts" explores the concept of meaning-making in human life and its contrast with artificial intelligence (AI). Drawing on Mikhail Bakhtin's philosophy, the episode delves into how humans construct meaning through their unique experiences, contexts, and subjective interpretations, a process Bakhtin refers to as "consummation."
The episode illustrates this with an example of two people experiencing a woman singing near a bus stop, highlighting how each individual's perspective and background inform their interpretation of the event. It argues that while humans are constantly assembling experiences into meaningful wholes, AI systems tend...2024-01-0808 min Local DisturbancesLocal Disturbances - Shorts #10 - Technologies of Reoccupation and Restoration"Episode 10: Technologies of Reoccupation and Restoration" from "Local Disturbances: Shorts" delves into the relationship between humans, technology, and the environment, reflecting on the historical and cultural implications of land use. The episode draws on the personal story of the host’s family, who were involved in the great Matheson Fire of 1916 in Northern Ontario, to illustrate the Western perspective of land as a set of rights rather than responsibilities.
The episode contrasts this Western view with Indigenous perspectives, which see land as entailing a set of responsibilities, exemplified by the Indigenous people's efforts to restore and return the gifts of th...2024-01-0808 min
Local DisturbancesLocal Disturbances - Shorts #10 - Technologies of Reoccupation and Restoration"Episode 10: Technologies of Reoccupation and Restoration" from "Local Disturbances: Shorts" delves into the relationship between humans, technology, and the environment, reflecting on the historical and cultural implications of land use. The episode draws on the personal story of the host’s family, who were involved in the great Matheson Fire of 1916 in Northern Ontario, to illustrate the Western perspective of land as a set of rights rather than responsibilities.
The episode contrasts this Western view with Indigenous perspectives, which see land as entailing a set of responsibilities, exemplified by the Indigenous people's efforts to restore and return the gifts of th...2024-01-0808 min Local DisturbancesLocal Disturbances - Shorts #9 - Play and Algorithmic Culture"Episode 9: Play and Algorithmic Culture" from "Local Disturbances: Shorts" delves into the concept of play as a potential form of resistance to the automation and algorithmic shaping of our lives. It suggests that play, being an activity without a direct objective, could disorder the assumptions of systems designed around efficiency and growth.
The episode illustrates how humans navigate different spaces by adapting to, avoiding, or resisting their rules. It proposes play as a fourth response category, one that shows indifference to a system's desires and offers little useful data for automated systems to learn from.
An experiment conducted by UKAI...2024-01-0406 min
Local DisturbancesLocal Disturbances - Shorts #9 - Play and Algorithmic Culture"Episode 9: Play and Algorithmic Culture" from "Local Disturbances: Shorts" delves into the concept of play as a potential form of resistance to the automation and algorithmic shaping of our lives. It suggests that play, being an activity without a direct objective, could disorder the assumptions of systems designed around efficiency and growth.
The episode illustrates how humans navigate different spaces by adapting to, avoiding, or resisting their rules. It proposes play as a fourth response category, one that shows indifference to a system's desires and offers little useful data for automated systems to learn from.
An experiment conducted by UKAI...2024-01-0406 min Local DisturbancesLocal Disturbances - Shorts #8 - Technologies of Care"Episode 8: Technologies of Care" from "Local Disturbances: Shorts" reflects on the human-centric approach to technology and AI, inspired by works like Jer Thorp’s "Living in Data" and Kate Crawford’s "Atlas of AI". It emphasizes starting with the vision of the world we want to live in and then shaping technology to fit that vision, rather than the other way around.
The episode highlights the work of the Maitri Platform, a global initiative that coordinated resources and support to improve equity in the COVID-19 response. Maitri's work showcased the human capacity for care, especially in reaching marginalized groups like thos...2024-01-0406 min
Local DisturbancesLocal Disturbances - Shorts #8 - Technologies of Care"Episode 8: Technologies of Care" from "Local Disturbances: Shorts" reflects on the human-centric approach to technology and AI, inspired by works like Jer Thorp’s "Living in Data" and Kate Crawford’s "Atlas of AI". It emphasizes starting with the vision of the world we want to live in and then shaping technology to fit that vision, rather than the other way around.
The episode highlights the work of the Maitri Platform, a global initiative that coordinated resources and support to improve equity in the COVID-19 response. Maitri's work showcased the human capacity for care, especially in reaching marginalized groups like thos...2024-01-0406 min Local DisturbancesLocal Disturbances - Shorts #7 - Diasporic AIWe explore the creation and impact of symbolic languages in the context of artificial intelligence and cultural diversity. We look at how communities and subcultures, historically and currently, use unique systems like slang, hand signals, and visual symbols to communicate outside official systems. The project, "Please Don’t Understand This," led in collaboration with the Goethe-Institut Toronto and the Canada Council for the Arts, aimed to develop new collective sense-making approaches for AI and algorithmic culture, drawing from diverse communities.
The project involved artists from different regions, including a refugee camp in Malawi and cities like Beijing and Cairo, to cr...2024-01-0410 min
Local DisturbancesLocal Disturbances - Shorts #7 - Diasporic AIWe explore the creation and impact of symbolic languages in the context of artificial intelligence and cultural diversity. We look at how communities and subcultures, historically and currently, use unique systems like slang, hand signals, and visual symbols to communicate outside official systems. The project, "Please Don’t Understand This," led in collaboration with the Goethe-Institut Toronto and the Canada Council for the Arts, aimed to develop new collective sense-making approaches for AI and algorithmic culture, drawing from diverse communities.
The project involved artists from different regions, including a refugee camp in Malawi and cities like Beijing and Cairo, to cr...2024-01-0410 min Local DisturbancesLocal Disturbances - Shorts #6 - Are you a bot?This episode from "Local Disturbances: Shorts" discusses the concept of interiority and its erosion in the age of artificial intelligence and automated interactions. Interiority, the inner character or nature of a person, is foundational to our understanding of and interactions with others. However, with the rise of bots and automated systems, there's a growing tendency to question the humanity and conscious internal life of others, especially in digital interactions.
The proliferation of bots, which accounted for 37.2% of internet users in 2020, has led to doubts about whether interactions are with real humans. This uncertainty can lead to the dehumanization of others...2024-01-0308 min
Local DisturbancesLocal Disturbances - Shorts #6 - Are you a bot?This episode from "Local Disturbances: Shorts" discusses the concept of interiority and its erosion in the age of artificial intelligence and automated interactions. Interiority, the inner character or nature of a person, is foundational to our understanding of and interactions with others. However, with the rise of bots and automated systems, there's a growing tendency to question the humanity and conscious internal life of others, especially in digital interactions.
The proliferation of bots, which accounted for 37.2% of internet users in 2020, has led to doubts about whether interactions are with real humans. This uncertainty can lead to the dehumanization of others...2024-01-0308 min Local DisturbancesLocal Disturbances - Shorts #5 - Culture, AI, and DisorderThis episode from "Local Disturbances: Shorts" explores the concept of conviviality in relation to AI, drawing on Ivan Illich's ideas. Illich defines conviviality as creative, autonomous interactions among people and their environment, contrasting with industrial productivity. The podcast discusses the tension between centralizing (centripetal) and decentralizing (centrifugal) forces in society and language, and how AI influences this balance.
Language is used as an example to illustrate these forces. Official language rules represent centralizing forces, while individual expressions and context-specific usages demonstrate decentralizing tendencies. Historical examples, like the standardization of French and the blending of languages in England, highlight how language...2024-01-0310 min
Local DisturbancesLocal Disturbances - Shorts #5 - Culture, AI, and DisorderThis episode from "Local Disturbances: Shorts" explores the concept of conviviality in relation to AI, drawing on Ivan Illich's ideas. Illich defines conviviality as creative, autonomous interactions among people and their environment, contrasting with industrial productivity. The podcast discusses the tension between centralizing (centripetal) and decentralizing (centrifugal) forces in society and language, and how AI influences this balance.
Language is used as an example to illustrate these forces. Official language rules represent centralizing forces, while individual expressions and context-specific usages demonstrate decentralizing tendencies. Historical examples, like the standardization of French and the blending of languages in England, highlight how language...2024-01-0310 min Local DisturbancesLocal Disturbances - Shorts #4 - What is the Role of the Arts in AI?This episode from "Local Disturbances: Shorts" focuses on the intersection of AI, art, and culture. It discusses how artificial intelligence is disrupting traditional modes of artistic expression and cultural engagement, and the necessity for artists to actively participate in exploring and critiquing these technologies.
Drawing on Mikhail Bakhtin's concepts, the episode emphasizes the role of the arts in contesting official ideologies, particularly those emphasizing growth and efficiency. It critiques how algorithms have been designed to produce a monotone aesthetic of agreeableness, limiting the diversity and creativity in artistic expression. This trend towards homogenization is counter to the reflective and contemplative...2024-01-0313 min
Local DisturbancesLocal Disturbances - Shorts #4 - What is the Role of the Arts in AI?This episode from "Local Disturbances: Shorts" focuses on the intersection of AI, art, and culture. It discusses how artificial intelligence is disrupting traditional modes of artistic expression and cultural engagement, and the necessity for artists to actively participate in exploring and critiquing these technologies.
Drawing on Mikhail Bakhtin's concepts, the episode emphasizes the role of the arts in contesting official ideologies, particularly those emphasizing growth and efficiency. It critiques how algorithms have been designed to produce a monotone aesthetic of agreeableness, limiting the diversity and creativity in artistic expression. This trend towards homogenization is counter to the reflective and contemplative...2024-01-0313 min Local DisturbancesThe Computer is your Redacted: Episode 1, Hot Brown BeverageWelcome to The Computer is Your Redacted, where you can listen as four experts in artificial intelligence, technology, and culture play the classic role-playing game Paranoia! and navigate a horrible and occasionally hilarious dystopia. Remember, everything is improvised …. and only our players decide where the story goes next.
Developed by the Goethe-Institut Toronto and program lead Jerrold McGrath
The Computer is Your Redacted presented by UKAI Projects and the Goethe-Institut Toronto
Players are Ian Garrett, Yasmeen Nematt Alla, Catherine Stinson, and Martin Ryan
Production are Max Cotter and Aleda DeRoche (Brainchild), Jess Forrest (Castle If), and Jess Gurd (the voice of...2023-10-1646 min
Local DisturbancesThe Computer is your Redacted: Episode 1, Hot Brown BeverageWelcome to The Computer is Your Redacted, where you can listen as four experts in artificial intelligence, technology, and culture play the classic role-playing game Paranoia! and navigate a horrible and occasionally hilarious dystopia. Remember, everything is improvised …. and only our players decide where the story goes next.
Developed by the Goethe-Institut Toronto and program lead Jerrold McGrath
The Computer is Your Redacted presented by UKAI Projects and the Goethe-Institut Toronto
Players are Ian Garrett, Yasmeen Nematt Alla, Catherine Stinson, and Martin Ryan
Production are Max Cotter and Aleda DeRoche (Brainchild), Jess Forrest (Castle If), and Jess Gurd (the voice of...2023-10-1646 min Local DisturbancesThe Computer is your Redacted: Episode 2, Innagadavida!Welcome to The Computer is Your Redacted, where you can listen as four experts in artificial intelligence, technology, and culture play the classic role-playing game Paranoia! and navigate a horrible and occasionally hilarious dystopia. Remember, everything is improvised …. and only our players decide where the story goes next.
Developed by the Goethe-Institut Toronto and program lead Jerrold McGrath
The Computer is Your Redacted presented by UKAI Projects and the Goethe-Institut Toronto
Players are Ian Garrett, Yasmeen Nematt Alla, Catherine Stinson, and Martin Ryan
Production are Max Cotter and Aleda DeRoche (Brainchild), Jess Forrest (Castle If), and Jess Gurd (the voice of...2023-10-1640 min
Local DisturbancesThe Computer is your Redacted: Episode 2, Innagadavida!Welcome to The Computer is Your Redacted, where you can listen as four experts in artificial intelligence, technology, and culture play the classic role-playing game Paranoia! and navigate a horrible and occasionally hilarious dystopia. Remember, everything is improvised …. and only our players decide where the story goes next.
Developed by the Goethe-Institut Toronto and program lead Jerrold McGrath
The Computer is Your Redacted presented by UKAI Projects and the Goethe-Institut Toronto
Players are Ian Garrett, Yasmeen Nematt Alla, Catherine Stinson, and Martin Ryan
Production are Max Cotter and Aleda DeRoche (Brainchild), Jess Forrest (Castle If), and Jess Gurd (the voice of...2023-10-1640 min Local DisturbancesThe Computer is your Redacted: Episode 3, The End?Welcome to The Computer is Your Redacted, where you can listen as four experts in artificial intelligence, technology, and culture play the classic role-playing game Paranoia! and navigate a horrible and occasionally hilarious dystopia. Remember, everything is improvised …. and only our players decide where the story goes next.
Developed by the Goethe-Institut Toronto and program lead Jerrold McGrath
The Computer is Your Redacted presented by UKAI Projects and the Goethe-Institut Toronto
Players are Ian Garrett, Yasmeen Nematt Alla, Catherine Stinson, and Martin Ryan
Production are Max Cotter and Aleda DeRoche (Brainchild), Jess Forrest (Castle If), and Jess Gurd (the voice of...2023-10-1645 min
Local DisturbancesThe Computer is your Redacted: Episode 3, The End?Welcome to The Computer is Your Redacted, where you can listen as four experts in artificial intelligence, technology, and culture play the classic role-playing game Paranoia! and navigate a horrible and occasionally hilarious dystopia. Remember, everything is improvised …. and only our players decide where the story goes next.
Developed by the Goethe-Institut Toronto and program lead Jerrold McGrath
The Computer is Your Redacted presented by UKAI Projects and the Goethe-Institut Toronto
Players are Ian Garrett, Yasmeen Nematt Alla, Catherine Stinson, and Martin Ryan
Production are Max Cotter and Aleda DeRoche (Brainchild), Jess Forrest (Castle If), and Jess Gurd (the voice of...2023-10-1645 min Travel with Amateur Traveler PodcastTravel to Hikone and Gifu, JapanHear about travel to Hikone and Gifu in Central Japan as the Amateur Traveler talks to Miyuki Seguchi from the Japan Experts Podcast about he home region of Japan where she is a tour guide.Why should you visit Central Japan?Miyuki says, "A lot of travelers from North America or the West when they travel to Japan, they will stay in Japan for two to three weeks, and they usually travel from the eastern part of Japan to the western part of Japan or vice versa, but most of them do not stop off...2023-07-2248 min
Travel with Amateur Traveler PodcastTravel to Hikone and Gifu, JapanHear about travel to Hikone and Gifu in Central Japan as the Amateur Traveler talks to Miyuki Seguchi from the Japan Experts Podcast about he home region of Japan where she is a tour guide.Why should you visit Central Japan?Miyuki says, "A lot of travelers from North America or the West when they travel to Japan, they will stay in Japan for two to three weeks, and they usually travel from the eastern part of Japan to the western part of Japan or vice versa, but most of them do not stop off...2023-07-2248 min 米拉秘密講SE2EP2-<米拉講美食>融化人心的《舞伎家的料理人》,分享高雄晶英飯店Ukai懷石料理這集還是要繼續講吃的。Part1:舞伎家的料理人,Netflix上可以看 導演:是枝裕和Part2: 被幸福圍繞的聖誕夜,分享高雄晶英飯店Ukai Kaiseki 懷石料理的心得這次增加了一個小花絮單元,大家要聽完喔!想看最完整的照片請到米拉秘密寫任何建議或是批評指教,或是想聽什麼,歡迎來信mimitalk2021@gmail.comSpotify/Apple podcast/google podcast: 米拉秘密講Blog: https://mimitalk2021.wordpress.comIG: mimitalk20212023-02-1818 min
米拉秘密講SE2EP2-<米拉講美食>融化人心的《舞伎家的料理人》,分享高雄晶英飯店Ukai懷石料理這集還是要繼續講吃的。Part1:舞伎家的料理人,Netflix上可以看 導演:是枝裕和Part2: 被幸福圍繞的聖誕夜,分享高雄晶英飯店Ukai Kaiseki 懷石料理的心得這次增加了一個小花絮單元,大家要聽完喔!想看最完整的照片請到米拉秘密寫任何建議或是批評指教,或是想聽什麼,歡迎來信mimitalk2021@gmail.comSpotify/Apple podcast/google podcast: 米拉秘密講Blog: https://mimitalk2021.wordpress.comIG: mimitalk20212023-02-1818 min Life Without UsLuisa Ji and Luc Lalande on Community Futures"We need community now more than ever” — Luc LalondeLuisa Ji is a multi-disciplinary creative, designer, and strategist. Luc Lalande is the Innovator-in-Residence at the Rideau-Rockcliffe Community Resource Centre. They join Valery to unpack the topic of ‘Community Futures’ from unique, but complementary perspectives. In this episode:* The barriers to community-building innovation found in many existing institutions * Why local, low barrier opportunities to engage in innovation and future visioning through the arts are essential to make sure we imagine the inclusive community futures we all need* A community...2022-11-1549 min
Life Without UsLuisa Ji and Luc Lalande on Community Futures"We need community now more than ever” — Luc LalondeLuisa Ji is a multi-disciplinary creative, designer, and strategist. Luc Lalande is the Innovator-in-Residence at the Rideau-Rockcliffe Community Resource Centre. They join Valery to unpack the topic of ‘Community Futures’ from unique, but complementary perspectives. In this episode:* The barriers to community-building innovation found in many existing institutions * Why local, low barrier opportunities to engage in innovation and future visioning through the arts are essential to make sure we imagine the inclusive community futures we all need* A community...2022-11-1549 min Lost Without JapanPlanning your trip to Gifu Japan | LWJ Season 2 Episode 4Lost Without Japan Season 2 Episode 4: Day Trip to Gifu, Japan w/ Night Fishing on the Nagara River TimeStamp for start of our talk on Gifu 5:55 Link to Google Doc that includes Google maps for all cities covered on Lost Without Japan, as well as the link to Amazon for travel purchase recommendations and other useful information for your travel to Japan. https://goo.gl/maps/CiguZ4ZXKJxcd72u7 Gifu Festivals Link: https://gifujets.weebly.com/festivals-and-events-128070.html Nagaragawa Onsen Network: https://nagaragawa.org/en/stay Song of the Show: TSUKI...2022-10-1743 min
Lost Without JapanPlanning your trip to Gifu Japan | LWJ Season 2 Episode 4Lost Without Japan Season 2 Episode 4: Day Trip to Gifu, Japan w/ Night Fishing on the Nagara River TimeStamp for start of our talk on Gifu 5:55 Link to Google Doc that includes Google maps for all cities covered on Lost Without Japan, as well as the link to Amazon for travel purchase recommendations and other useful information for your travel to Japan. https://goo.gl/maps/CiguZ4ZXKJxcd72u7 Gifu Festivals Link: https://gifujets.weebly.com/festivals-and-events-128070.html Nagaragawa Onsen Network: https://nagaragawa.org/en/stay Song of the Show: TSUKI...2022-10-1743 min 寶可孟卡好【Fine Dining】高雄UKAI亭.用餐心得分享!|寶可孟卡好S10EP17高雄UKAI亭是位於「晶英國際行館」內的餐廳。官網寫說「引進榮獲世界米其林星級殊榮肯定的UKAI餐飲團隊之鐵板燒、懷石與西餐餐廳,追求料理的臨場感,努力縮短烹調到餐桌的時間差,透過熱度與聲音,把「新鮮」傳遞給客人。」這是真的嗎?經過我的體驗,我可以大聲的跟大家說:「沒錯!」它不僅具有五星飯店的餐廳水準,更是超過我過往所吃過的所有Fine Dining-從我到行館一樓開始,他們的服務就是100%沒話說的貼心,到三樓餐廳門口的報到與帶位,乃至於入座後的悉心講解酒水單、菜單,還有席間一一介紹菜色,幾乎是以1:1的人力在為每一位客人服務,座前有鐵板燒師傅一一為你烹調美食,後面有服務生不斷為你更換刀叉與斟水,就像在跳一場華麗的雙人舞-原來,真正的Fine Dining就是這樣子!此餐無信用卡折扣,我使用將來銀行將將卡賺5%將來N點。 -- 高雄UKAI亭官網:https://bit.ly/3Bh68ND 圖文介紹:(近期登場) 將來銀行將將卡介紹:https://bit.ly/3zZPsd5 立即入手一張將將卡:https://lihi1.com/vmEmN -- 小額贊助支持本節目: https://open.firstory.me/join/ckdpsqfmxifcf0862q6efk1qa 留言告訴我你對這一集的想法: https://open.firstory.me/user/ckdpsqfmxifcf0862q6efk1qa/comments Powered by Firstory Hosting2022-07-2624 min
寶可孟卡好【Fine Dining】高雄UKAI亭.用餐心得分享!|寶可孟卡好S10EP17高雄UKAI亭是位於「晶英國際行館」內的餐廳。官網寫說「引進榮獲世界米其林星級殊榮肯定的UKAI餐飲團隊之鐵板燒、懷石與西餐餐廳,追求料理的臨場感,努力縮短烹調到餐桌的時間差,透過熱度與聲音,把「新鮮」傳遞給客人。」這是真的嗎?經過我的體驗,我可以大聲的跟大家說:「沒錯!」它不僅具有五星飯店的餐廳水準,更是超過我過往所吃過的所有Fine Dining-從我到行館一樓開始,他們的服務就是100%沒話說的貼心,到三樓餐廳門口的報到與帶位,乃至於入座後的悉心講解酒水單、菜單,還有席間一一介紹菜色,幾乎是以1:1的人力在為每一位客人服務,座前有鐵板燒師傅一一為你烹調美食,後面有服務生不斷為你更換刀叉與斟水,就像在跳一場華麗的雙人舞-原來,真正的Fine Dining就是這樣子!此餐無信用卡折扣,我使用將來銀行將將卡賺5%將來N點。 -- 高雄UKAI亭官網:https://bit.ly/3Bh68ND 圖文介紹:(近期登場) 將來銀行將將卡介紹:https://bit.ly/3zZPsd5 立即入手一張將將卡:https://lihi1.com/vmEmN -- 小額贊助支持本節目: https://open.firstory.me/join/ckdpsqfmxifcf0862q6efk1qa 留言告訴我你對這一集的想法: https://open.firstory.me/user/ckdpsqfmxifcf0862q6efk1qa/comments Powered by Firstory Hosting2022-07-2624 min The Haikyuu SummitS1E9 - "A Toss to the Ace"The reviews are in! We're so excited to have feedback from you! Send us your feedback and we might feature it on an upcoming episode 👀
Also this week: we realize we're older than coach Ukai and have an existential crisis, and us being just as hard on Asahi as Daichi is (sorry....😬)2021-09-2433 min
The Haikyuu SummitS1E9 - "A Toss to the Ace"The reviews are in! We're so excited to have feedback from you! Send us your feedback and we might feature it on an upcoming episode 👀
Also this week: we realize we're older than coach Ukai and have an existential crisis, and us being just as hard on Asahi as Daichi is (sorry....😬)2021-09-2433 min PAPERSKY「THINKING CLOUDS with Lucas B.B. 」「ひとり登山のススメ。自分なりのスタイルで山を楽しむには Guest:ジェリー鵜飼〈後編〉」#002イラストレーターのジェリー鵜飼さんをゲストにお迎えする回〈後編〉です。ジェリー鵜飼さんがアウトドアにハマったきっかけや、必要最小限の荷物で登山する“ウルトラライト”の魅力、こだわりのギアなど、多角的な視点で山を楽しむ方法を掘り下げます。
『THINKING CLOUDS』はホスト役をつとめる「PAPERSKY」編集長のルーカスB.B.と、文具・雑貨メーカー「HIGHTIDE」の稲垣葵が、「思考の旅」をキーワードに、さまざまな分野で活躍するゲストを招いて、旅の話や、世界各地の魅力的な人、カルチャーなど、頭に浮かぶあれこれを共有してトークを楽しむ番組です。
次回のゲストはアウトドアブランド〈andwander(アンドワンダー)〉のデザイナー・森美穂子さんです。ぜひお楽しみに!
毎月第1・3月曜日に新エピソードを配信。
【ゲスト】
ジェリー鵜飼(Jerry Ukai)
1971年生まれ。静岡県出身。イラストレーター、アートディレクター。主な仕事はアウトドアメーカーやファッションブランドのカタログや広告のディレクション、アートワークの提供。アートユニット「ウルトラヘビー」のメンバーとしても精力的に作品を生み出している。
【ホスト】
ルーカス B.B.(Lucas B.B.)
1971年、アメリカ・ボルティモア生まれ。サンフランシスコ育ち。カリフォルニア大学卒業後、バックパックひとつで来日。フリーランスのライターとして活動しながら、1996年に日英バイリンガルのカルチャー誌『TOKION』を創刊。2002年にトラベル・ライフスタイル誌『PAPERSKY』を創刊し、“エスノ・トラベル”という新たな視点で、時間、自然、文化をシームレスに融合させ、未来とつなぐフレッシュなメディアを創造している。
稲垣葵(Aoi Inagaki)
福岡発の文具・雑貨メーカー「HIGHTIDE」企画担当。「PAPERSKY」のプロダクトライン「PAPERSKY TRAVEL TOOLS」の制作に「HIGHTIDE」が携わることから「PAPERSKY Podcast」に出演。旅やアウトドアは勉強中。
PAPERSKY Japan Stories : https://papersky.jp/
PAPERSKY STORE : https://store.papersky.jp/2021-07-1936 min
PAPERSKY「THINKING CLOUDS with Lucas B.B. 」「ひとり登山のススメ。自分なりのスタイルで山を楽しむには Guest:ジェリー鵜飼〈後編〉」#002イラストレーターのジェリー鵜飼さんをゲストにお迎えする回〈後編〉です。ジェリー鵜飼さんがアウトドアにハマったきっかけや、必要最小限の荷物で登山する“ウルトラライト”の魅力、こだわりのギアなど、多角的な視点で山を楽しむ方法を掘り下げます。
『THINKING CLOUDS』はホスト役をつとめる「PAPERSKY」編集長のルーカスB.B.と、文具・雑貨メーカー「HIGHTIDE」の稲垣葵が、「思考の旅」をキーワードに、さまざまな分野で活躍するゲストを招いて、旅の話や、世界各地の魅力的な人、カルチャーなど、頭に浮かぶあれこれを共有してトークを楽しむ番組です。
次回のゲストはアウトドアブランド〈andwander(アンドワンダー)〉のデザイナー・森美穂子さんです。ぜひお楽しみに!
毎月第1・3月曜日に新エピソードを配信。
【ゲスト】
ジェリー鵜飼(Jerry Ukai)
1971年生まれ。静岡県出身。イラストレーター、アートディレクター。主な仕事はアウトドアメーカーやファッションブランドのカタログや広告のディレクション、アートワークの提供。アートユニット「ウルトラヘビー」のメンバーとしても精力的に作品を生み出している。
【ホスト】
ルーカス B.B.(Lucas B.B.)
1971年、アメリカ・ボルティモア生まれ。サンフランシスコ育ち。カリフォルニア大学卒業後、バックパックひとつで来日。フリーランスのライターとして活動しながら、1996年に日英バイリンガルのカルチャー誌『TOKION』を創刊。2002年にトラベル・ライフスタイル誌『PAPERSKY』を創刊し、“エスノ・トラベル”という新たな視点で、時間、自然、文化をシームレスに融合させ、未来とつなぐフレッシュなメディアを創造している。
稲垣葵(Aoi Inagaki)
福岡発の文具・雑貨メーカー「HIGHTIDE」企画担当。「PAPERSKY」のプロダクトライン「PAPERSKY TRAVEL TOOLS」の制作に「HIGHTIDE」が携わることから「PAPERSKY Podcast」に出演。旅やアウトドアは勉強中。
PAPERSKY Japan Stories : https://papersky.jp/
PAPERSKY STORE : https://store.papersky.jp/2021-07-1936 min PAPERSKY「THINKING CLOUDS with Lucas B.B. 」「アート、デザイン、音楽、そして“アウトドア”に行き着くまで Guest:ジェリー鵜飼〈前編〉」#001記念すべき第1回目のゲストはイラストレーターのジェリー鵜飼さんです。ルーカスB.B.とも付き合いの長いジェリー鵜飼さんに、お二人の出会いから、「PAPERSKY」誕生までのエピソード、一緒に手がけてきた様々なプロジェクトのお話を伺いながら、時代が変わっても変わらないお互いの価値観についてまで話を広げていきます。
『THINKING CLOUDS』はホスト役をつとめる「PAPERSKY」編集長のルーカスB.B.と、文具・雑貨メーカー「HIGHTIDE」の稲垣葵が、「思考の旅」をキーワードに、さまざまな分野で活躍するゲストを招いて、旅の話や、世界各地の魅力的な人、カルチャーなど、頭に浮かぶあれこれを共有してトークを楽しむ番組です。
次回はジェリー鵜飼さんの回〈後編〉です。ジェリー鵜飼さんのアウトドアの楽しみ方から、最近ハマっていること、旅に対する考え方までを伺っていきます。ぜひお楽しみに!
毎月第1・3月曜日に新エピソードを配信。
【ゲスト】
ジェリー鵜飼(Jerry Ukai)
1971年生まれ。静岡県出身。イラストレーター、アートディレクター。主な仕事はアウトドアメーカーやファッションブランドのカタログや広告のディレクション、アートワークの提供。アートユニット「ウルトラヘビー」のメンバーとしても精力的に作品を生み出している。
【ホスト】
ルーカス B.B.(Lucas B.B.)
1971年、アメリカ・ボルティモア生まれ。サンフランシスコ育ち。カリフォルニア大学卒業後、バックパックひとつで来日。フリーランスのライターとして活動しながら、1996年に日英バイリンガルのカルチャー誌『TOKION』を創刊。2002年にトラベル・ライフスタイル誌『PAPERSKY』を創刊し、“エスノ・トラベル”という新たな視点で、時間、自然、文化をシームレスに融合させ、未来とつなぐフレッシュなメディアを創造している。
稲垣葵(Aoi Inagaki)
福岡発の文具・雑貨メーカー「HIGHTIDE」企画担当。「PAPERSKY」のプロダクトライン「PAPERSKY TRAVEL TOOLS」の制作に「HIGHTIDE」が携わることから「PAPERSKY Podcast」に出演。旅やアウトドアは勉強中。
PAPERSKY Japan Stories : https://papersky.jp/
PAPERSKY STORE : https://store.papersky.jp/2021-07-0518 min
PAPERSKY「THINKING CLOUDS with Lucas B.B. 」「アート、デザイン、音楽、そして“アウトドア”に行き着くまで Guest:ジェリー鵜飼〈前編〉」#001記念すべき第1回目のゲストはイラストレーターのジェリー鵜飼さんです。ルーカスB.B.とも付き合いの長いジェリー鵜飼さんに、お二人の出会いから、「PAPERSKY」誕生までのエピソード、一緒に手がけてきた様々なプロジェクトのお話を伺いながら、時代が変わっても変わらないお互いの価値観についてまで話を広げていきます。
『THINKING CLOUDS』はホスト役をつとめる「PAPERSKY」編集長のルーカスB.B.と、文具・雑貨メーカー「HIGHTIDE」の稲垣葵が、「思考の旅」をキーワードに、さまざまな分野で活躍するゲストを招いて、旅の話や、世界各地の魅力的な人、カルチャーなど、頭に浮かぶあれこれを共有してトークを楽しむ番組です。
次回はジェリー鵜飼さんの回〈後編〉です。ジェリー鵜飼さんのアウトドアの楽しみ方から、最近ハマっていること、旅に対する考え方までを伺っていきます。ぜひお楽しみに!
毎月第1・3月曜日に新エピソードを配信。
【ゲスト】
ジェリー鵜飼(Jerry Ukai)
1971年生まれ。静岡県出身。イラストレーター、アートディレクター。主な仕事はアウトドアメーカーやファッションブランドのカタログや広告のディレクション、アートワークの提供。アートユニット「ウルトラヘビー」のメンバーとしても精力的に作品を生み出している。
【ホスト】
ルーカス B.B.(Lucas B.B.)
1971年、アメリカ・ボルティモア生まれ。サンフランシスコ育ち。カリフォルニア大学卒業後、バックパックひとつで来日。フリーランスのライターとして活動しながら、1996年に日英バイリンガルのカルチャー誌『TOKION』を創刊。2002年にトラベル・ライフスタイル誌『PAPERSKY』を創刊し、“エスノ・トラベル”という新たな視点で、時間、自然、文化をシームレスに融合させ、未来とつなぐフレッシュなメディアを創造している。
稲垣葵(Aoi Inagaki)
福岡発の文具・雑貨メーカー「HIGHTIDE」企画担当。「PAPERSKY」のプロダクトライン「PAPERSKY TRAVEL TOOLS」の制作に「HIGHTIDE」が携わることから「PAPERSKY Podcast」に出演。旅やアウトドアは勉強中。
PAPERSKY Japan Stories : https://papersky.jp/
PAPERSKY STORE : https://store.papersky.jp/2021-07-0518 min Pesan dan TrendBahas Buku "Dua Orang yang Bertemu untuk Saling Meny(L)ukai"Santri dalam karya. Episode ini kita bahas buku fiksi.2021-06-1453 min
Pesan dan TrendBahas Buku "Dua Orang yang Bertemu untuk Saling Meny(L)ukai"Santri dalam karya. Episode ini kita bahas buku fiksi.2021-06-1453 min Sightseeing JapanThe Chubu RegionThe Chubu region is located in central Honshu between the Kanto and Kansai regions. It is characterized by rugged mountains and also contains an important symbol of Japan, Mount Fuji. Join Jason and Paul as they explore the amazing things to see and do in this oft-overlooked region of Japan!Topics Covered:History: Tokaido Trail — Nakasendo TrailAichi Prefecture: Nagoya Castle — Inuyama Castle — Atsuta Jingu — Tokugawa Art Museum — SCMaglev and Railway Park — Toyota Kaikan Museum — Nagashima Resort — Atera-no-Nanataki Falls — Miso Nikomi Udon — Gohei MochiShizuoka Prefecture: World Tea Museum — Kunozan Toshogu Shrine...2021-04-261h 01
Sightseeing JapanThe Chubu RegionThe Chubu region is located in central Honshu between the Kanto and Kansai regions. It is characterized by rugged mountains and also contains an important symbol of Japan, Mount Fuji. Join Jason and Paul as they explore the amazing things to see and do in this oft-overlooked region of Japan!Topics Covered:History: Tokaido Trail — Nakasendo TrailAichi Prefecture: Nagoya Castle — Inuyama Castle — Atsuta Jingu — Tokugawa Art Museum — SCMaglev and Railway Park — Toyota Kaikan Museum — Nagashima Resort — Atera-no-Nanataki Falls — Miso Nikomi Udon — Gohei MochiShizuoka Prefecture: World Tea Museum — Kunozan Toshogu Shrine...2021-04-261h 01 Radio mazā lasītavaJāņa Pauļuka vēstules Felicitai, kas tagad publicētas grāmatā "Mīlu Tevi"Viņš pasludināja sevi par „gleznotāju karali. Radīja leģendas pats par sevi. Mainīja identitāti no labi situēta Rīgas franta līdz pusbadā dzīvojošam māksliniekam. Viņš rakstīja vēstules Viņai. Gleznotājs Jānis Pauļuks māksliniecei Felicitai Pauļukai.
Mākslas zinātnieces Ingrīdas Burānes vadīts Gundars Āboliņš lasa Jāņa vēstules Felicitai, kas tagad publicētas grāmatā „Mīlu Tevi". Izdevis apgāds "Zinātne".
Raidījumu atbalsta:2021-04-2524 min
Radio mazā lasītavaJāņa Pauļuka vēstules Felicitai, kas tagad publicētas grāmatā "Mīlu Tevi"Viņš pasludināja sevi par „gleznotāju karali. Radīja leģendas pats par sevi. Mainīja identitāti no labi situēta Rīgas franta līdz pusbadā dzīvojošam māksliniekam. Viņš rakstīja vēstules Viņai. Gleznotājs Jānis Pauļuks māksliniecei Felicitai Pauļukai.
Mākslas zinātnieces Ingrīdas Burānes vadīts Gundars Āboliņš lasa Jāņa vēstules Felicitai, kas tagad publicētas grāmatā „Mīlu Tevi". Izdevis apgāds "Zinātne".
Raidījumu atbalsta:2021-04-2524 min Bonsai Mirai: AsymmetryWorld War Bonsai: Remembrance and ResilienceFor this episode of Asymmetry, the Mirai team visited the Pacific Bonsai Museum to shine a light on the current exhibit, World War Bonsai: remembrance and resilience. Eve Sczechowski sits down with museum curator Aarin Packard and researcher Nancy Ukai, who is the director of a digital project called 50 Objects/Stories: The American Japanese Incarceration. Listen and understand Nancy's perspective as a Japanese American with family members who were unjustly incarcerated during the 1940's, and understand how this history has majorly influenced the story of American bonsai.
To see more about the exhibit at the Pacific Bonsai M...2021-04-241h 51
Bonsai Mirai: AsymmetryWorld War Bonsai: Remembrance and ResilienceFor this episode of Asymmetry, the Mirai team visited the Pacific Bonsai Museum to shine a light on the current exhibit, World War Bonsai: remembrance and resilience. Eve Sczechowski sits down with museum curator Aarin Packard and researcher Nancy Ukai, who is the director of a digital project called 50 Objects/Stories: The American Japanese Incarceration. Listen and understand Nancy's perspective as a Japanese American with family members who were unjustly incarcerated during the 1940's, and understand how this history has majorly influenced the story of American bonsai.
To see more about the exhibit at the Pacific Bonsai M...2021-04-241h 51 Persepsi LainNgabuburead#1 Dua Orang yang Bertemu untuk Saling Meny(L)ukai (Sofwatillah)Ngabuburead adalah segmen spesial ramadhan Podcast Persepsi Lain. Di sini gue akan bahas tentang buku yang pernah gue baca, gue pelajari dan gue tulis. Buku pertama yang gue bahas adalah buku gue yang berjudul "Dua Orang yang Bertemu untuk Saling Meny(L)ukai. Sila simak2021-04-1315 min
Persepsi LainNgabuburead#1 Dua Orang yang Bertemu untuk Saling Meny(L)ukai (Sofwatillah)Ngabuburead adalah segmen spesial ramadhan Podcast Persepsi Lain. Di sini gue akan bahas tentang buku yang pernah gue baca, gue pelajari dan gue tulis. Buku pertama yang gue bahas adalah buku gue yang berjudul "Dua Orang yang Bertemu untuk Saling Meny(L)ukai. Sila simak2021-04-1315 min Can You Dig ItEpisode 5: A Coward's AnxietyThis episode Elaine and Bee discuss the very best sensei, the third year's dynamics, and Ukai's nasty ass feet.
---
Support this podcast: https://podcasters.spotify.com/pod/show/elaine-blank/support2021-04-0627 min
Can You Dig ItEpisode 5: A Coward's AnxietyThis episode Elaine and Bee discuss the very best sensei, the third year's dynamics, and Ukai's nasty ass feet.
---
Support this podcast: https://podcasters.spotify.com/pod/show/elaine-blank/support2021-04-0627 min 🇯🇵Learn Japanese with Haikyuu!!🏐ハイキューで学ぶ日本語Kita's 👑Legendary Speech on "Geniuses", Ukai, the "Crow Breeder"? -🏐Learn Japanese with Haikyuu!!Join me learning Japanese with the sports manga/anime masterpiece!
Twitter: https://twitter.com/WithHaikyuu
*On Twitter you can find all the written explanations for the topics covered on the podcast!
Discord: https://discord.gg/Xqf6FKVPca2021-03-3016 min
🇯🇵Learn Japanese with Haikyuu!!🏐ハイキューで学ぶ日本語Kita's 👑Legendary Speech on "Geniuses", Ukai, the "Crow Breeder"? -🏐Learn Japanese with Haikyuu!!Join me learning Japanese with the sports manga/anime masterpiece!
Twitter: https://twitter.com/WithHaikyuu
*On Twitter you can find all the written explanations for the topics covered on the podcast!
Discord: https://discord.gg/Xqf6FKVPca2021-03-3016 min poetic technologyletter 003: this is a remix of emo-goods 😀😭🙃😣😍Welcome emotional beings,To be honest, it’s getting very emotional here. Been rolling deep in the COVID feels — the isolation, the SADs : it went so deep, to the edges of the heart. Turmoiled in and out of emotional chaos. It feels almost impossible to feel warmth, aka care and love. It feels difficult to share at these times. Like feeling frozen. 😔Alas : Time unthaws. Seasons are cycles. Sometimes, it’s about surviving, not thriving — as my sister lovingly shared with me. The winter season demonstrates that vividly; when observing nature mammals are hibernating...2021-03-2412 min
poetic technologyletter 003: this is a remix of emo-goods 😀😭🙃😣😍Welcome emotional beings,To be honest, it’s getting very emotional here. Been rolling deep in the COVID feels — the isolation, the SADs : it went so deep, to the edges of the heart. Turmoiled in and out of emotional chaos. It feels almost impossible to feel warmth, aka care and love. It feels difficult to share at these times. Like feeling frozen. 😔Alas : Time unthaws. Seasons are cycles. Sometimes, it’s about surviving, not thriving — as my sister lovingly shared with me. The winter season demonstrates that vividly; when observing nature mammals are hibernating...2021-03-2412 min 🇯🇵Learn Japanese with Haikyuu!!🏐ハイキューで学ぶ日本語Japanese People's Favorite Verb 💃🏻"Mau", Ukai's Quote on "Serves to Score"-🏐Learn Japanese with Haikyuu!!Join me learning Japanese with the sports manga/anime masterpiece!
Twitter: https://twitter.com/WithHaikyuu
*On Twitter you can find all the written explanations for the topics covered on the podcast!
Discord: https://discord.gg/Xqf6FKVPca2021-03-0514 min
🇯🇵Learn Japanese with Haikyuu!!🏐ハイキューで学ぶ日本語Japanese People's Favorite Verb 💃🏻"Mau", Ukai's Quote on "Serves to Score"-🏐Learn Japanese with Haikyuu!!Join me learning Japanese with the sports manga/anime masterpiece!
Twitter: https://twitter.com/WithHaikyuu
*On Twitter you can find all the written explanations for the topics covered on the podcast!
Discord: https://discord.gg/Xqf6FKVPca2021-03-0514 min 🇯🇵Learn Japanese with Haikyuu!!🏐ハイキューで学ぶ日本語Tendou's "Baki-Baki Song" 💔 , Ukai Coach's Legendary "Heads-up" -🏐Learn Japanese with Haikyuu!!Hello Haikyuu!! homies😎 Join me learning Japanese with the sports manga/anime masterpiece!
Twitter: https://twitter.com/WithHaikyuu
【Summary】
-武田一鉄(たけだいってつ)is a reference to the legendary actor, 武田鉄矢(たけだてつや)
-武田 is a very common family name
-一鉄 literally means "first iron", sounds very masculine and old-fashioned
-常に上を向くスポーツ can be interpreted either as "a sport where you always look up" or"a sport that always looks up", but the latter one doesn't make sense so it's the first one.
-バキバキ is an onomatopoeia for the sound of some stick-like things broken into pieces
-いる's conditional form is いれ
2021-01-0720 min
🇯🇵Learn Japanese with Haikyuu!!🏐ハイキューで学ぶ日本語Tendou's "Baki-Baki Song" 💔 , Ukai Coach's Legendary "Heads-up" -🏐Learn Japanese with Haikyuu!!Hello Haikyuu!! homies😎 Join me learning Japanese with the sports manga/anime masterpiece!
Twitter: https://twitter.com/WithHaikyuu
【Summary】
-武田一鉄(たけだいってつ)is a reference to the legendary actor, 武田鉄矢(たけだてつや)
-武田 is a very common family name
-一鉄 literally means "first iron", sounds very masculine and old-fashioned
-常に上を向くスポーツ can be interpreted either as "a sport where you always look up" or"a sport that always looks up", but the latter one doesn't make sense so it's the first one.
-バキバキ is an onomatopoeia for the sound of some stick-like things broken into pieces
-いる's conditional form is いれ
2021-01-0720 min Slow Blink Anime Podcast71. Haikyuu! To the Top! E15 'Found' - REVIEW | KARASUNO USES ALL THEIR TRICKS AGAINST THE MIYA TWINSAnother Haikyuu! To the Top! review! Today we are covering Episode 15 "Found". Karasuno is forced to use all the skills they've accumulated during their training to just barely keep up with Inarizaki.
Hinata has been chosen by Coach Ukai to dedicatedly block Miya Osumu!
Haikyuu! To the Top! Episode 15 - Found
FOLLOW US!
Twitter: https://twitter.com/slowblinkanime
Facebook: https://www.facebook.com/slowblinkanime/
Instagram: https://www.instagram.com/slowblinkanime/
2020-10-1400 min
Slow Blink Anime Podcast71. Haikyuu! To the Top! E15 'Found' - REVIEW | KARASUNO USES ALL THEIR TRICKS AGAINST THE MIYA TWINSAnother Haikyuu! To the Top! review! Today we are covering Episode 15 "Found". Karasuno is forced to use all the skills they've accumulated during their training to just barely keep up with Inarizaki.
Hinata has been chosen by Coach Ukai to dedicatedly block Miya Osumu!
Haikyuu! To the Top! Episode 15 - Found
FOLLOW US!
Twitter: https://twitter.com/slowblinkanime
Facebook: https://www.facebook.com/slowblinkanime/
Instagram: https://www.instagram.com/slowblinkanime/
2020-10-1400 min Slow Blink Anime Podcast69. Haikyuu! To the Top! E14 'Rhythm' REVIEW | THE MIYA TWINS ARE SCARY GOOD!Haikyuu To the Top is back with Episode 14, 'Rhythm'! The 2nd cour kicks off with an exciting start of the Karasuno vs Inarizaki game and both sides are showing what the got!
Miya Atsumu is the stand out character this match as he is described as a "dual-wielder" by Coach Ukai. Being able to spike serve and jump float serve he is a huge problem for the Karasuno players.
Inarizaki controls the flow of the game with their intimidating Cheer Section. How will Karasuno handle the...2020-10-0900 min
Slow Blink Anime Podcast69. Haikyuu! To the Top! E14 'Rhythm' REVIEW | THE MIYA TWINS ARE SCARY GOOD!Haikyuu To the Top is back with Episode 14, 'Rhythm'! The 2nd cour kicks off with an exciting start of the Karasuno vs Inarizaki game and both sides are showing what the got!
Miya Atsumu is the stand out character this match as he is described as a "dual-wielder" by Coach Ukai. Being able to spike serve and jump float serve he is a huge problem for the Karasuno players.
Inarizaki controls the flow of the game with their intimidating Cheer Section. How will Karasuno handle the...2020-10-0900 min This Amazing Story16. Meagan Putts – Life at 6000m Below Sea LevelOn today’s show I was super lucky to do a deep-dive into life at 6000 meters below sea level, with Deep-Sea Marine Biologist, Communications specialist, and Remotely Operated Vehicle navigator, Meagan Putts! Meagan is part of a team of researchers at the University of Hawaii, that is building a better understanding of life in the deep oceans, which are still largely unexplored and unknown.Meagan’s main area of expertise is in deep-sea coral and sponge commnunities, but she clearly has a love for all things oceanic. Her ground-breaking research is changing the way we think about the...2020-09-3000 min
This Amazing Story16. Meagan Putts – Life at 6000m Below Sea LevelOn today’s show I was super lucky to do a deep-dive into life at 6000 meters below sea level, with Deep-Sea Marine Biologist, Communications specialist, and Remotely Operated Vehicle navigator, Meagan Putts! Meagan is part of a team of researchers at the University of Hawaii, that is building a better understanding of life in the deep oceans, which are still largely unexplored and unknown.Meagan’s main area of expertise is in deep-sea coral and sponge commnunities, but she clearly has a love for all things oceanic. Her ground-breaking research is changing the way we think about the...2020-09-3000 min Hopcast.jp#2 沼津、伊豆の旅#2 沼津、伊豆の旅
2020/9/9
夫婦で行った沼津〜伊豆の旅
ルカワイン、ラーメンロタス、ヤナギダマサミ、窪田さんのみかん農園、The Old Bus、西伊豆がヤバイ、お魚天国、RePuBrew、サウナしきじ、ラーメンやんぐ、Jerry Ukaiなどなど。今年は静岡に縁があるようです。2020-09-0730 min
Hopcast.jp#2 沼津、伊豆の旅#2 沼津、伊豆の旅
2020/9/9
夫婦で行った沼津〜伊豆の旅
ルカワイン、ラーメンロタス、ヤナギダマサミ、窪田さんのみかん農園、The Old Bus、西伊豆がヤバイ、お魚天国、RePuBrew、サウナしきじ、ラーメンやんぐ、Jerry Ukaiなどなど。今年は静岡に縁があるようです。2020-09-0730 min Atrask LietuvąAtrask Lietuvą. Tradicinė lietuviška dūminė pirtis "Vabalynėje".Šalčininkų r., Vilkiškio k., įsikūrusioje sveikos gyvensenos kaimo turizmo sodyboje "Vabalynė" galima gerai išsiperti. Ir ne tik... Valandėlę kitą nusnausti bičių namelyje, išsimaudyti Merkio upėje, pabraidyti po nešienautą pievą, kurioje nėra erkių, paskanauti ekologiškų arbatų ar kito maisto. Sodybos šeimininkai Ramunė ir Egidijus Žukai juokauja, kad jų pavardė įpareigoja domėtis vabzdžių pasauliu ir apie juos skleisti gerą žinią.Ved. Jolanta Jurkūnienė2020-09-0552 min
Atrask LietuvąAtrask Lietuvą. Tradicinė lietuviška dūminė pirtis "Vabalynėje".Šalčininkų r., Vilkiškio k., įsikūrusioje sveikos gyvensenos kaimo turizmo sodyboje "Vabalynė" galima gerai išsiperti. Ir ne tik... Valandėlę kitą nusnausti bičių namelyje, išsimaudyti Merkio upėje, pabraidyti po nešienautą pievą, kurioje nėra erkių, paskanauti ekologiškų arbatų ar kito maisto. Sodybos šeimininkai Ramunė ir Egidijus Žukai juokauja, kad jų pavardė įpareigoja domėtis vabzdžių pasauliu ir apie juos skleisti gerą žinią.Ved. Jolanta Jurkūnienė2020-09-0552 min @ayobaikbareng🎧 [3 Agustus ] Podcast Spesial | Persiapan UKAI, Yuk Bisa Yuk!Apoteker .. Siapa Takut?2020-08-0321 min
@ayobaikbareng🎧 [3 Agustus ] Podcast Spesial | Persiapan UKAI, Yuk Bisa Yuk!Apoteker .. Siapa Takut?2020-08-0321 min Listen Japanese - The Times with TMYEP003 - My home town; GifuAbout My hometown, GIFU.
Hello, this is TOMOYA from JAPAN. I hope my casting helps your learning Japanese.
Please keep subscribing me and follow me on twitter @WithTmy
Hints
Gifu is central of Japan. I live in Gifu City in Gifu Prefecture.
Ukai is one of the famous things of Gifu. It's Japanese traditional fishing style.
It has performed at Nagara-river. It history has more than 1300 years.
Near to Nagara-rive, there is mt. Kinka and there is Gifu castle on the top of the mountain.2020-05-1307 min
Listen Japanese - The Times with TMYEP003 - My home town; GifuAbout My hometown, GIFU.
Hello, this is TOMOYA from JAPAN. I hope my casting helps your learning Japanese.
Please keep subscribing me and follow me on twitter @WithTmy
Hints
Gifu is central of Japan. I live in Gifu City in Gifu Prefecture.
Ukai is one of the famous things of Gifu. It's Japanese traditional fishing style.
It has performed at Nagara-river. It history has more than 1300 years.
Near to Nagara-rive, there is mt. Kinka and there is Gifu castle on the top of the mountain.2020-05-1307 min JournalSpotting#04 March '20 Round Up: Bicycles, stopping Ace-i, HIV injectables, IHD management, CFS/ME, ITU tips and... BathsAre you trying to keep up with the general medicine literature but you are saturated with Covid Coughs, Swabs, Oxygenation, Isolation, Ventilation, and the Mortality of the Nation? Your ears are in the right place as we bring you last months most relevant (and sometimes less relevant) general medicine articles.---------------------------------------------------------- In this month's episode......why we shouldn't leave all the cycling to work to the anaesthetists...Association of injury-related hospital admissions with commuting by bicycle in the UK: a prospective population-based study. BMJ.https://doi.org/10.1136/bmj.m3362020-04-1450 min
JournalSpotting#04 March '20 Round Up: Bicycles, stopping Ace-i, HIV injectables, IHD management, CFS/ME, ITU tips and... BathsAre you trying to keep up with the general medicine literature but you are saturated with Covid Coughs, Swabs, Oxygenation, Isolation, Ventilation, and the Mortality of the Nation? Your ears are in the right place as we bring you last months most relevant (and sometimes less relevant) general medicine articles.---------------------------------------------------------- In this month's episode......why we shouldn't leave all the cycling to work to the anaesthetists...Association of injury-related hospital admissions with commuting by bicycle in the UK: a prospective population-based study. BMJ.https://doi.org/10.1136/bmj.m3362020-04-1450 min Pernah KuliahLEMBAGA DAKWAH KAMPUSMasna dan Gilang cerita tentang pengalaman aktif di organisasi kampus / UKM. Mereka berdua adalah alumni Rohis Kampus atau yang dulu disebut UKAI, kalau sekarang namanya LEMBAGA DAKWAH KAMPUS. 2020-01-0325 min
Pernah KuliahLEMBAGA DAKWAH KAMPUSMasna dan Gilang cerita tentang pengalaman aktif di organisasi kampus / UKM. Mereka berdua adalah alumni Rohis Kampus atau yang dulu disebut UKAI, kalau sekarang namanya LEMBAGA DAKWAH KAMPUS. 2020-01-0325 min Aplīša saruna | pulsometrs.lvJeļena Prokopčuka Aplīša sarunā!Jeļenai Prokopčukai skriešanas aprindās nekāds pieteikums nav vajadzīgs. Jeņenas panākumu saraksts ir ļoti garš – dalības Olimpiskajās spēlēs, divas uzvaras Ņujorkas maratonā, uzvara Osakas maratonā Japānā, daudzi Top3 daudzos citos pasaules maratonos un pusmaratonos. Jeļenai Prokopčukai pieder Latvijas rekordi visās distancēs no 3000m līdz maratonam. Jā, Jeļena Prokopčuka nav tikai Latvijas labākā skrējēja, viņa ir Pasaules līmeņa sportiste.
Sarunājoties ar Jeļenu mēs izrunājāt gan to, kas šobrīd aktuāls, gan mēģināju saprast, kas ir viņ...2019-09-2344 min
Aplīša saruna | pulsometrs.lvJeļena Prokopčuka Aplīša sarunā!Jeļenai Prokopčukai skriešanas aprindās nekāds pieteikums nav vajadzīgs. Jeņenas panākumu saraksts ir ļoti garš – dalības Olimpiskajās spēlēs, divas uzvaras Ņujorkas maratonā, uzvara Osakas maratonā Japānā, daudzi Top3 daudzos citos pasaules maratonos un pusmaratonos. Jeļenai Prokopčukai pieder Latvijas rekordi visās distancēs no 3000m līdz maratonam. Jā, Jeļena Prokopčuka nav tikai Latvijas labākā skrējēja, viņa ir Pasaules līmeņa sportiste.
Sarunājoties ar Jeļenu mēs izrunājāt gan to, kas šobrīd aktuāls, gan mēģināju saprast, kas ir viņ...2019-09-2344 min Real Nerd Hours059: MUSK MELONS, INCORRECT FOLKLORE AND DANGEROUS SEX MANEUVERS feat @PiggyNukka
The gang has returned, this time with Nikki in tow! You already know this episode has a ton of anime talk in it.
There are a lot of announcements to go over at the top of the episode so keep your ears peeled for some great stuff. One of those great things is we finally have a P.O. Box address to give out. If you want to send us stuff, look below.
Chad started Altered Cabron and he’s digging it! Nikki comes through with this anime season in review and drops a little sa...2018-02-142h 04
Real Nerd Hours059: MUSK MELONS, INCORRECT FOLKLORE AND DANGEROUS SEX MANEUVERS feat @PiggyNukka
The gang has returned, this time with Nikki in tow! You already know this episode has a ton of anime talk in it.
There are a lot of announcements to go over at the top of the episode so keep your ears peeled for some great stuff. One of those great things is we finally have a P.O. Box address to give out. If you want to send us stuff, look below.
Chad started Altered Cabron and he’s digging it! Nikki comes through with this anime season in review and drops a little sa...2018-02-142h 04 Arancio Music _ em25xp _ phreakwavezmurders from brighton vs acid from berlin_june2017this is music out of my vinyl stash which really had lots of influence into my musical orientation/and also timeless forgotten weapons which mostly only exist on that fewpressings from nowadays_
sorry for some really badass hard to handle cuts which really pissesd me off... but i decided to post it anyway with all those unperfect unsynced treasures and myself on acid! enjoy!
dotcom006 bside track4 neta -ukai seiji nippin out ep
tresor /skandinavia edition103 proaudio neil landstrumm track>?
chan n mikes 005- michael forshaw- track?
dont know yet
blueprint 2016 -1996 disc2
chan n mikes records michael forshaw chan 002
...2017-06-011h 03
Arancio Music _ em25xp _ phreakwavezmurders from brighton vs acid from berlin_june2017this is music out of my vinyl stash which really had lots of influence into my musical orientation/and also timeless forgotten weapons which mostly only exist on that fewpressings from nowadays_
sorry for some really badass hard to handle cuts which really pissesd me off... but i decided to post it anyway with all those unperfect unsynced treasures and myself on acid! enjoy!
dotcom006 bside track4 neta -ukai seiji nippin out ep
tresor /skandinavia edition103 proaudio neil landstrumm track>?
chan n mikes 005- michael forshaw- track?
dont know yet
blueprint 2016 -1996 disc2
chan n mikes records michael forshaw chan 002
...2017-06-011h 03![Black Hat Briefings, Japan 2004 [Audio] Presentations from the security conference](http://media.blackhat.com/bh-japan-04/bh-japan-04-itunes.jpg) Black Hat Briefings, Japan 2004 [Audio] Presentations from the security conferenceYuji Ukai: Environment Dependencies in Windows Exploitation(Japanese)"In the case of vulnerabilities which allow the execution of arbitrary machine code, the reliability of exploitation is swayed by the type of vulnerability, the conditions surrounding the vulnerable code, and the attack vector, among other considerations. The reliability of exploitation an important factor for those attempting to exploit a vulnerability'especially so for worm and virus writers'so therefore it is also an important consideration for the threat analysis of security vulnerabilities.
In Japan, some public institutions and non-governmental enterprises are providing detailed information and threat analyses of vulnerabilities, exploits, and worms. Because the majority of the systems in Japan run...2006-11-0141 min
Black Hat Briefings, Japan 2004 [Audio] Presentations from the security conferenceYuji Ukai: Environment Dependencies in Windows Exploitation(Japanese)"In the case of vulnerabilities which allow the execution of arbitrary machine code, the reliability of exploitation is swayed by the type of vulnerability, the conditions surrounding the vulnerable code, and the attack vector, among other considerations. The reliability of exploitation an important factor for those attempting to exploit a vulnerability'especially so for worm and virus writers'so therefore it is also an important consideration for the threat analysis of security vulnerabilities.
In Japan, some public institutions and non-governmental enterprises are providing detailed information and threat analyses of vulnerabilities, exploits, and worms. Because the majority of the systems in Japan run...2006-11-0141 min